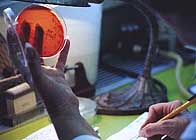
サムネイル

疾患・特集
感染症
感染症に関する記事をご紹介します。感染症の正しい知識を身につけることで、予防や改善にお役立てください。

麻疹(はしか)は感染力が強く、発熱、咳、鼻水や発疹などの症状が現れます。7~10日で治まりますが、妊婦の場合は流産や早産が起きることもあります。空気感染するため、確実に予防するには、子供も成人も予防接種を2回受けることが必要です。予防接種を受けられる医療施設は、厚生労働省検疫所のウェブサイトで検索できます。 目次 免疫のない人が感染すると、発症する確率はほぼ100%! 発熱や発疹が主な症状だが、妊婦は流産や早産のリスクも… 麻疹の症状が治まるのは、発症から7~10日後 感染者と同じ空間にいるだけで感染する「空気感染」 手洗い・うがい・マスクでは防げない!有効なのは予防接種 とても簡単!予防接種を受けられる医療機関の見つけ方 免疫のない人が感染すると、発症する確率はほぼ100%! 2016年の8月から9月にかけて、突如として国内で流行した麻疹(はしか)。例年、麻疹の流行は、春から初夏にかけて、0~1歳の子供を中心に起きます。それに対して、2016年の流行で中心となったのは成人で、9月18日の時点で患者数が130人を超えました。これは、前年2015年の年間患者数の3倍以上に相当します。流行の経緯として、関西の空港を中心に集団感染が起き、感染者の移動に伴い関東でも感染が広まったと報じられています。 麻疹は、麻疹ウイルスに感染して引き起こされる感染症です。その感染力は非常に強く、免疫をもたない人が感染すると、ほぼ100%発症すると言われています。一度発症すれば免疫ができ、その後は一生かかることがありません。 発熱や発疹が主な症状だが、妊婦は流産や早産のリスクも… 麻疹は、ウイルスに感染してからの10~12日の間は、症状は特に現れません。潜伏期間と呼ばれるこの無症状の期間を過ぎると、発熱、咳、鼻水、のどの痛み、目の充血などの風邪に似た症状が現れ、口の中に1mmほどの小さな発疹ができます。熱は2~3日続いた後にいったん下がるものの、再び上がり39度以上の高熱となり、それと同時に全身に赤い発疹が現れます。麻疹にかかると、合併症として肺炎や中耳炎などほかの病気にも同時にかかりやすく、脳炎や肺炎による死亡が患者1,000人に1人の割合でまれに起きると言われています。 妊婦が麻疹にかかった場合は重症化しやすく、流産や早産が起きることがあります。胎児奇形が引き起こされることはないものの、胎児の発育異常や羊水量の異常、新生児麻疹(分娩時罹患)などが起きる可能性があるとされています。 麻疹の症状が治まるのは、発症から7~10日後 麻疹を根本的に治す方法はないため、治療においては、症状を抑える対症療法が行われます。麻疹の症状が治まるのは、肺炎や中耳炎などのほかの病気にかかっていなければ、発症から7~10日後。肺炎や中耳炎などにかかっている場合は、それらの治療のために抗菌剤の投与が行われます。 感染者と同じ空間にいるだけで感染する「空気感染」 麻疹ウイルスにはいくつかの感染経路がありますが、もっとも特徴的だと言えるのは「空気感染」です。感染者の咳やくしゃみで飛んだしぶきの水分が蒸発すると、そこに含まれていたウイルスが空気中に浮遊します。そのウイルスを吸い込むことで起きる空気感染は、感染者と同じ空間にいるだけで起きる恐れがあります。たとえ体育館のような広い場所であっても、そこに感染者が1人でもいれば、その場にいる全員に感染のリスクがあるのです。 空気感染以外に、ウイルスが含まれた咳やくしゃみのしぶきが体内に入って感染する「飛沫感染」や、手に付着したウイルスが体内に入って感染する「接触感染」でも、麻疹にかかります。 手洗い・うがい・マスクでは防げない!有効なのは予防接種 空気感染する麻疹は、手洗い、うがい、マスクだけでは十分に予防することができません。麻疹の予防方法として有効なのは、麻疹ワクチンによる予防接種です。接種は2回受けることが必要で、1回だけでは免疫が十分にできず、確実な予防効果が得られません。厚生労働省が推奨している子供の予防接種のタイミングは、1回目は1歳になったときで、2回目は小学校入学前の1年間です。この期間の接種費用は公費で負担されるため、無料で受けることができます。自治体によっては、条件を満たせば中学生・高校生でも無料で接種できることがあるので、詳しくは各自治体に問い合わせましょう。 子供の頃に受けなかった人も、成人後に受けることで免疫ができますが、費用は自己負担となります。一般的に費用は5,000~10,000円とされていますが、医療施設によって異なるので、各施設に問い合わせましょう。なお、麻疹の予防接種は、麻疹の単独ワクチンか、MRワクチン(麻疹・風疹混合ワクチン)のどちらかが用いられます。 予防効果とは異なるワクチン接種後の反応は副反応と呼ばれ、麻疹ワクチンの場合は発熱や発疹などが現れることがあります。副反応が起きた場合は、医師に相談しましょう。 妊婦は麻疹ワクチンの接種を受けることができません。麻疹にかかったことがなく、また予防接種を2回受けていない場合は免疫ができておらず、麻疹にかかる可能性が高いので、流行地域での外出はできるだけ控えましょう。女性は妊娠していなくても胎児への影響を考慮して、接種後2ヵ月ほどは避妊する必要があります。 とても簡単!予防接種を受けられる医療機関の見つけ方 過去に麻疹にかかったことがある人は、すでに免疫ができているため予防接種を受ける必要はありません。かかったことがあるかどうか、あるいは接種を2回受けたかはっきりと分からない場合は、医師に相談しましょう。かかったことがある人が麻疹ワクチンを接種しても、予防効果に変化はなく、副反応が強く出ることもありません。 麻疹ワクチンを取り扱っているのは、小児科やワクチン外来、海外渡航者外来などです。予防接種を受けられる医療機関が分からない場合は、厚生労働省検疫所のウェブサイトで検索するとよいでしょう。 麻疹の予防接種を受けることで、発症を防げるだけでなく、自分が感染源となってまわりの人に感染させてしまうのを防ぐこともできます。麻疹の免疫ができていない人は妊婦を除いて、ぜひ予防接種を受けましょう。 公開日:2016/10/11

ヘルペスは母子間で感染することがあります。大人にとってはそれほど重症にはならないヘルペスですが、赤ちゃんが感染すると、皮膚が柔らかく、かきむしってしまったりして、症状がひどくなる場合もあります。母子間でヘルペスがどのように感染してしまうのでしょうか。 目次 母子感染に気を付けたいヘルペスウイルス 授乳で感染する場合も 赤ちゃんのヘルペスの症状とは 母子感染に気を付けたいヘルペスウイルス ウイルスが体の中に潜伏し、体調が悪くなると発症するヘルペス。普段ならそれほど深刻に考えないものですが、赤ちゃんを育てているお母さんにとっては心配なものです。 ヘルペスは母子間で感染することもあります。大人にとってはそれほど重症にはならないヘルペスですが、赤ちゃんに感染した場合は、皮膚が柔らかく、かきむしってしまったりして、症状がひどくなる場合もあります。 このため、赤ちゃんにはヘルペスがうつらないように、できる限りの注意をしたいものです。それでは、母子間でのヘルペスの感染はどのようにして起こってしまうのでしょうか。 授乳で感染する場合も 単純ヘルペスウイルスは、母乳を通じて感染した例も報告されていて、感染の可能性がまったくないとは言えません。特に重症の場合には、ウイルスが母乳に存在する場合もあります。 とはいえ、通常はこのような可能性は低いと考えられており、絶対に授乳してはいけないということはありません。心配な場合は医師に相談するのがよいでしょう。 母乳からの感染よりも気をつけたいのは、患部への接触による感染です。キスや頬ずりはもちろん、ヘルペスに触った手で赤ちゃんに触るだけで感染することもあります。また、感染時に使ったタオル・食器の共有なども避けた方がいいです。お母さんがヘルペスを発症しているときは、赤ちゃんになるべく触れないように注意し、もし赤ちゃんと触れ合うのであれば手をよく洗うようにしましょう。 赤ちゃんのヘルペスの症状とは ここで、赤ちゃんにヘルペスが感染したときの、症状について紹介します。 ヘルペスウイルスに初めて感染した乳幼児に最も多い症状が「ヘルペス性歯肉口内炎」です。急に高熱が出て、口の中に水疱ができたり、歯茎が腫れ上がって出血したりすることもあります。赤ちゃんの場合は脱水症状を起こしやすいため、重症の場合には入院して点滴治療を行う必要があります。 また、アトピー性皮膚炎の赤ちゃんがヘルペスに感染した場合は、皮膚の抵抗力が弱いため重症化しやすくなっています。このようなときに、赤ちゃんが患部をひっかいてしまうと、さらにほかの場所にも感染が広がってしまうため、注意が必要です。 ウイルスのついた手で目を触ってしまうなどして、ウイルスが目に入ると「ヘルペス性角膜炎」を起こす可能性もあります。ヘルペス性角膜炎は、再発を繰り返すと視力障害が残ったり、角膜が薄くなって穿孔(せんこう)したりすることもあるため、赤ちゃんが患部を触った手で目を触らないように、注意してみてあげましょう。 単純ヘルペスの場合には、放っておけば2週間くらいでかさぶたになり、ポロっと取れて治ります。しかし、乳幼児の場合は、皮膚が柔らかくて敏感なので、放置しておくと、それがシミのような跡になってしまうこともあります。それを防ぐには、抗ウイルス薬やぬり薬を処方してもらい、早期に治療することが大切です。赤ちゃんがヘルペスにかかったかな、と思うような症状がある場合には、早めに病院を受診するようにしましょう。 ■関連記事 要注意!新生児のヘルペス もしヘルペスにかかったらどうしよう? 原因は、症状は?ヘルペスはこんな病気 公開日:2016/09/26

ヘルペスは、身近にあるウイルスが原因で多くの方が感染している珍しくはない病気です。そんな身近なヘルペスは、できてしまってから薬で治療するだけでなく、普段の食事に気をつけることで発症の予防を助けることができる可能性があります。 目次 身近に潜むヘルペス 食べ物で免疫力を持続させてヘルペスを予防する ヘルペスとアルギニン 身近に潜むヘルペス ヘルペスと聞くと何か特別な病気と思われる方もいらっしゃると思います。ですが、身近にあるウイルスが原因で多くの方が感染している珍しくはない病気なのです。 例えば幼い頃多くの方が発症する水疱瘡、そして大人も発症する帯状疱疹などもヘルペスウイルスに分類されます。有名な口唇ヘルペスや性器ヘルペスなどもあります。そんな身近なヘルペスは、できてしまってから薬で治療するだけでなく、普段の食事に気をつけることで発症の予防を助けることができるかもしれません。 食べ物で免疫力を持続させてヘルペスを予防する ヘルペスは体の免疫力が低下したときや何らかの刺激を受けたときに症状を発症することが多いと言われています。そのため、免疫力を高めて持続させて行くのも発症予防のひとつと言えそうです。 免疫力をアップさせるために必要な栄養素として、ビタミン類や鉄分などがあります。そのほかの栄養素に亜鉛、セレン、リコピン、フコイダン、ゴマリグナン、乳酸菌、オリゴ糖などがあります。 ビタミンAは油に溶けやすいビタミンなので、野菜炒めなどで吸収力をアップさせましょう。ビタミンAは、皮膚や粘膜の代謝を正常に保つはたらきをします。 ビタミンCは水に溶けやすい栄養素です。最近ではデトックスウォーターとして、いちごやキウイなどのフルーツとミントなどのハーブを水にいれて飲むことが流行中です。ビタミンCは免疫細胞のはたらきを高め、鉄分の吸収率を高めてくれます。鉄分は免疫細胞の殺菌能力を活性化します。 ビタミンEも、油に溶けやすいビタミンです。抗酸化作用があり皮膚の代謝を高めます。 ビタミンB2は水に溶けやすいビタミンです。不足すると口角炎や口内炎などがおこりやすくなります。しっかりと摂取すれば粘膜を正常にはたらかせます。 これらのビタミンは身近な食品に含まれていますので、積極的に摂取すれば予防の一助となりそうです。 ヘルペスとアルギニン ヘルペスと言えば、アルギニンというアミノ酸成分がクローズアップされています。アルギニンを含む食べ物として、大豆類、肉類、中でも豚ゼラチン(皮に多く含まれる)や牛肉、鶏肉、エビやマグロ、かつお節、ごまなどが挙げられます。 さまざまな説がありますが、アルギニンを摂取しすぎるとヘルペスを発症してしまうという説もあります。しかし、科学研究費助成事業研究成果報告書(平成25年6月13日)によると、アルギニンはヘルペスウイルスを不活化させるとの研究結果が報告されています。 まだ研究段階なので断定はできませんが、アルギニンを含む食べ物やサプリメントを摂取することで、ヘルペスの予防に役立つ可能性が出てきました。 アルギニンの過剰摂取は体に悪いので、適量を摂取することによって体の免疫力を高めヘルペスの発症を予防することが期待できます。また、発症してからもヘルペスを早く治す手助けとなることが期待できます。 ■関連記事 要注意!新生児のヘルペス もしヘルペスにかかったらどうしよう? 原因は、症状は?ヘルペスはこんな病気 公開日:2016/06/13

旅行や出張で海外に滞在しているときに体調を崩してしまったら?海外では、薬や応急処置用品を簡単に入手できない可能性もあるため、事前に用意しておくと安心です。海外で薬を買う場合の注意点もご紹介します。 目次 目的地によって、日本から持っていくべき薬が違う!? 医師から処方された薬は、英語の薬剤携行証明書を持っていくと安心 海外で「ニセ薬」を買わされないために、事前の確認が大切 目的地によって、日本から持っていくべき薬が違う!? 旅行や出張で海外に滞在しているときに、思いもよらず体調を崩してしまうことは、十分に考えられます。感染症が流行している地域であれば、事前に予防接種を受けていても、できるだけ感染のリスクを低くすることを意識しなくてはなりません。海外では、薬や応急処置用品を簡単に入手できない可能性があります。 かぜ薬(総合かぜ薬、痛み止め・解熱剤)と胃腸薬(一般胃腸薬、整腸剤)は、行き先を問わず携帯することが勧められます。欧州・北米・オセアニア以外では、下痢止めや便秘薬も加えると安心です。そのほか、目的地に応じて以下のような薬と応急処置用品を日本から持っていくことが勧められます。飛行機内で体調を崩すことを想定して、薬は機内持ち込み手荷物に入れましょう。 目的地別の渡航用セットの例 渡航のタイプ 対象地域 持っていくことが勧められる薬と応急処置用品 都市部・一般観光地・リゾ-ト地で感染症が少ない地域 欧州・北米・オセアニア 酔い止め、救急絆創膏 都市部・一般観光地・リゾ-ト地で感染症がある地域 アジア・中近東・アフリカの一部(エジプト・ナイロビ・南アフリカ・モロッコ)・ 南米の一部(アルゼンチン・チリなど) 酔い止め、かゆみ止め、消毒液、うがい薬、救急絆創膏、虫除けスプレー、蚊取線香(マラリアやデング熱流行地域) 感染症が多い地域 アフリカ全域・中南米 【マラリア予防薬】 メフロキンなど(前もって処方してもらい、服用期間は指示を守る) ※現地で薬剤を購入する場合は耐性や、ニセ薬のリスクに注意する 【その他】 酔い止め、かゆみ止め、消毒液、うがい薬、救急絆創膏、虫除けスプレー、蚊取線香、弾性包帯、滅菌ガ-ゼ、脱脂綿、体温計、ハサミ(機内持ち込み荷物には入れない)、ピンセット、毛抜き 感染症の蔓延している地域(冒険旅行/未開地踏破型) アジア(山間部、森林地帯)・アフリカ・南米(山間部、森林地帯) 【マラリア予防薬】 メフロキンなど(前もって処方してもらい、服用期間は指示を守る) ※現地で薬剤を購入する場合は耐性や、ニセ薬のリスクに注意する 【その他】 酔い止め、かゆみ止め、消毒液、うがい薬、救急絆創膏、虫除けスプレー、蚊取線香、弾性包帯、湿布薬、目薬、滅菌ガ-ゼ、脱脂綿、体温計、ハサミ(機内持ち込み荷物には入れない)、ピンセット、毛抜き、毒ヘビに咬まれた場合の救急セット(入手可能なら日本から持っていく) 出典:厚生労働省検疫所FORTHホームページ https://www.forth.go.jp/useful/attention/03.html 医師から処方された薬は、英語の薬剤携行証明書を持っていくと安心 テロ対策の影響により、海外への薬の持ち込みは厳しく取り締まられる傾向にあります。持ち込みが認められている薬を適正な量だけ持っていても、説明を求められる場面に遭遇するかもしれません。注射薬の場合は、覚せい剤と疑われる可能性もあります。そんなときに不要なトラブルを避けるため、OTC(薬局やドラッグストアで市販されている薬)は入国の際に説明ができるように、また自分で何の薬なのかが分かるように、元のパッケージのまま持っていきましょう。医師から処方された薬は、薬の名前(商品名および一般名)が記載された処方箋のコピーと、英語で書かれた薬剤携行証明書を持っていくと安心です。英語の薬剤携行証明書の発行は、処方をした医師に依頼するとよいでしょう。発行にかかる時間や費用は、各医療施設に事前にお問い合わせください。 薬によっては、渡航先への持ち込みが認められないことがあるので、事前に目的地の在日本大使館・領事館に確認しましょう。規制されている薬および注射薬は、処方した医師からレターヘッド付きの便箋(上部に医療機関名やロゴ、連絡先などが印刷されているもの)に説明を書いてもらうことが勧められます。 一部の向精神薬(抗うつ薬、抗不安薬、睡眠薬など)は、一定量を超えた飲み薬や注射剤を携帯する場合は、医療用麻薬と同様に出入国の際に申請が必要となります。申請が必要となる向精神薬の種類や量などは、厚生労働省地方厚生局麻薬取締部のWebサイトにてご確認いただくか、各地方厚生局にお問い合わせください。 海外で「ニセ薬」を買わされないために、事前の確認が大切 薬は日本から持っていくのがよいと分かっていても、海外で買わざるをえない状況になる可能性もあるでしょう。地域によっては、パッケージと中身の異なる、あるいは効果が薄い「ニセ薬」を買わされる恐れもあります。そんな事態を避けるために、海外で薬を買うときは以下を守りましょう。これらの行動は、ニセ薬を見破りやすくなるだけでなく、売り手に「警戒心の強いこの相手に、ニセ薬は売らないほうがよさそうだ」と思わせる効果も期待できます。 海外で薬を購入するときに注意したいこと ●可能な限り、許可を得ている薬局であることを確認して、購入の際に領収書を請求する ●極端に安い薬は買わない ●バラ売りの飲み薬は元のパッケージを見せてもらい、商品名・製品番号・有効期限を記録する ●薬剤名のつづりが間違っている、印刷の質が悪いなど、元のパッケージに問題がないか注意する ●箱に入った薬は、添付文書がついていることを確認する 公開日:2016/04/25

海外では、地域によっては感染症が流行していることもあります。海外に行く際は予防接種を受けましょう。海外でかかりやすい感染症と予防接種を受ける際のポイントをご紹介します。 目次 出発の1ヵ月前までには、どの予防接種を受けるべきか医療機関で相談を! 海外でかかりやすい感染症 予防接種による重い副反応はまれだが、体質などによっては医師に相談が必要 渡航先が冬の場合は、インフルエンザの予防接種も忘れずに! 出発の1ヵ月前までには、どの予防接種を受けるべきか医療機関で相談を! 海外旅行は、出発前の準備をしているときからワクワクした気持ちになるものです。しかし、海外は楽しいことばかりではありません。地域によっては、感染症が流行していることもあります。感染症にかからないようにするためには、予防接種を受けることが勧められます。国によっては入国する際に、特定の予防接種を受けたことの証明書を提示するよう求められることがあります。渡航しようとしている国で必要になるか、詳しくは在日大使館や検疫所などで事前に確認しましょう。 予防接種は複数回の注射が必要であり、また十分な免疫を獲得するには、接種後に一定の時間がかかります。そのためできれば出国の3ヵ月以上前、それが難しければ1ヵ月前までに、医療機関でどの予防接種を受けるべきか相談しましょう。受けることが勧められる予防接種は、渡航先や滞在期間によって異なります。厚生労働省検疫所のWebサイトに掲載されている「海外渡航で検討する予防接種の種類の目安」を参考にしてください。 海外でかかりやすい感染症 ■黄熱 感染経路 蚊が媒介 主な症状 発熱、黄疸 生活上の注意 ・皮膚を露出しない ・虫よけを塗る ・殺虫剤を散布する 予防接種の対象者 感染リスクのある地域に渡航する人 ■A型肝炎 感染経路 飲食物から感染 主な症状 発熱、黄疸、全身倦怠感 生活上の注意 ・水はミネラルウォーターを飲む ・加熱した料理を食べる 予防接種の対象者 途上国に中・長期(1ヵ月以上)滞在する人。特に40歳以下 ■B型肝炎 感染経路 性行為で感染 主な症状 発熱、黄疸、全身倦怠感 生活上の注意 ・行きずりの性行為を控える 予防接種の対象者 血液・体液に接触する可能性のある人 ■破傷風 感染経路 傷口から感染 主な症状 口が開かない、けいれん 生活上の注意 ・皮膚を露出しない 予防接種の対象者 冒険旅行などでけがをする可能性の高い人 ■狂犬病 感染経路 動物から感染 主な症状 恐水症(液体を飲もうとすると筋肉がけいれんするため水を恐れる)、けいれん 生活上の注意 ・動物に近寄らない 予防接種の対象者 イヌやキツネ、コウモリなどが多く、特に近くに医療機関がない地域へ行く人 動物研究者など、動物と直接接触する人 ■ポリオ 感染経路 飲食物から感染 主な症状 発熱、手足の麻痺 生活上の注意 ・水はミネラルウォーターを飲む ・加熱した料理を食べる 予防接種の対象者 流行地域に渡航する人 ■日本脳炎 感染経路 蚊が媒介 主な症状 発熱、意識障害 生活上の注意 ・皮膚を露出しない ・虫よけを塗る ・殺虫剤を散布する 予防接種の対象者 流行地域に長期滞在する人(主に東南アジアでブタを飼っている農村部) 予防接種による重い副反応はまれだが、体質などによっては医師に相談が必要 海外でかかりやすい感染症の予防接種は、検疫所や特定の内科、「トラベルクリニック」「予防接種外来」「トラベラーズ外来」などを掲げている医療機関で受けることができます。予防接種を受けられる医療機関は、厚生労働省検疫所のWebサイトにある予防接種実施機関検索などから探すことができます。 子供も、大人と同様に予防接種を受けることができます。小さな子供は病気に対する抵抗力が大人ほど強くないため、感染症が発症しやすく、また発症した際は重症化する可能性が高くなります。感染症のリスクが高い地域へ小さな子供を連れて行くときは、予防接種の必要性について、医師と相談しましょう。 医薬品の使用によって生じる好ましくない作用は「副作用」と呼ばれますが、ワクチンの使用における好ましくない作用は「副反応」と呼びます。予防接種を受けた後に、注射をした部位の腫れや痛みなどの軽い副反応は起きることがありますが、ショック症状やけいれんなどの重い副反応はまれにしか起きません。ただし、アレルギー体質の人や、以前に予防接種で副反応が起きたことがある人は、そのことを事前に医師に伝えましょう。また、妊婦には接種できないワクチンがあるので、妊娠していることも医師に伝える必要があります。 渡航先が冬の場合は、インフルエンザの予防接種も忘れずに! 海外でかかりやすい感染症の予防は万全でも、特に日本が夏の場合はつい忘れがちなのが、渡航先がインフルエンザのシーズンであること。インフルエンザが流行する時期は北半球が12~3月、南半球が6~9月ですが、熱帯地域では年間を通して流行していることもあります。旅行中に多くの時間を過ごすバスや飛行機などの中は密閉されているため、咳やくしゃみの飛沫を通して感染するインフルエンザのリスクが高い空間だと言えます。日本では、新たなシーズン用のインフルエンザワクチンの予防接種が可能となるのは、一般的に10月以降です。海外へ行くときだけに限りませんが、予防接種や手洗い・うがいなどで、インフルエンザの対策を忘れずにしましょう。 予防接種に健康保険は適用されず、自費払いとなります。ワクチンの種類や受ける施設によって異なりますが、インフルエンザを除いた海外でかかりやすい病気の予防接種は、一般的に1回につき5,000~10,000円の接種を2回行います。予防接種は、自分の身を守るために受けるものです。わずかな手間やお金を惜しんだばかりに、取り返しのつかないことになる恐れもあります。「滞在期間は短いから大丈夫」「まわりのみんなは受けていないから、自分も受ける必要はない」などと考えずに、受けることをお勧めします。 せっかくの楽しい海外旅行。健康には万全の備えをして、安心して旅をお楽しみください。 公開日:2016/04/25

ヘルペスは感染力が強いので、直接的な接触のほかに、ウイルスがついたタオルやグラスなどからも感染することがあります。感染しないための注意点を解説します。 目次 ヘルペスに感染しないためには? ヘルペスに感染してしまったら… ヘルペスに感染しないためには? ヘルペスとは、水ぶくれが集まった状態のことを指し、代表的なものには、単純ヘルペスウイルスによる口唇ヘルペスや性器ヘルペス、水痘・帯状疱疹ウイルスによる水ぼうそうや帯状疱疹などがあります。ヘルペスウイルスに一度感染すると、再発を繰り返しやすいため、できるならば感染を防ぎたいと思う方も多いでしょう。 感染症の予防方法としてよく知られているのが、予防接種ですが、残念ながら今のところ、単純ヘルペスへの感染を予防できるワクチンは開発されていません。このため現在の段階では、ヘルペスウイルスへの感染を防ぐには、ヘルペスウイルスを持つ人との接触に気をつけることが有効な手段となるでしょう。単純ヘルペスウイルスは感染力が強いので、直接的な接触のほかに、ウイルスがついたタオルやグラスなどからも感染することがあるので、注意が必要です。 ヘルペスに感染してしまったら… ヘルペスは一度感染すると、体調を崩したときなどに繰り返し発症します。このようなときに有効な成分が「リジン」です。ヘルペスウイルス保持の人がリジンを飲むことで、発症の確率を減らすことができた、ということが医療センターなどで実証されています。 リジンは蕎麦や牛肉に多く含まれており、サプリメントとしても商品化されているので、試してみるのもいいでしょう。また、ビタミンCや亜鉛には皮膚の修復作用があるため、この成分をリジンと一緒に摂取すると、より予防に効果的でしょう。 反対に、ヘルペスを引き起こしやすい食べ物にはナッツ、大豆、玄米、レーズン、エビなどがあります。これらの食べ物には、ヘルペスウイルスの栄養素となるアルギニンを多く含んでいるからです。 ヘルペスのみならず多くの病気にいえることですが、十分な睡眠、バランスのとれた食事、ストレスをためない、といったことも予防には大切なことです。 ■関連記事 要注意!新生児のヘルペス もしヘルペスにかかったらどうしよう? 原因は、症状は?ヘルペスはこんな病気 公開日:2016/03/22

唇の周辺などに水ぶくれを起こしたりするヘルペス。ヘルペスのウイルスの型による病気の特徴と、ワクチンの有効性について、ご紹介します。 目次 ヘルペスをワクチンで防ぐことはできるの? 単純ヘルペスウイルスワクチンは開発途中 ヘルペスをワクチンで防ぐことはできるの? 唇の周辺などに水ぶくれを起こしたりするヘルペス。ヘルペスウイルスには8種類のウイルスが知られていますが、代表的なものには、口唇ヘルペスを起こす単純ヘルペスウイルス1型、性器ヘルペスを起こす単純ヘルペスウイルス2型などがあります。 日本人では1型には50~70%、2型には5~10%の人が感染しているといわれていて、再発を繰り返すのが特徴です。一度感染していまうと再発を繰り返す、というのなら、感染する前に防ぐことができないものなの?という疑問も出てきます。 感染症に有効、といってまず思い浮かぶのが、ワクチンを用いた予防接種です。ヘルペスウイルスに有効なワクチンがあれば、問題解決!ところで、水ぼうそうの原因もヘルペスウイルスだと、聞いたことがありませんか?水ぼうそうには予防接種のワクチンがあります。 それでは、このワクチンを接種すれば、ヘルペスを防ぐことができるのでしょうか?ヘルペスのウイルスの型による病気の特徴と、ワクチンの有効性について、ご紹介しましょう。 単純ヘルペスウイルスワクチンは開発途中 前述のとおり、ヘルペスウイルスには8つの種類が確認されていて、口唇ヘルペスを引き起こすものと、水ぼうそうを引き起こすものでは、種類が異なります。 口唇ヘルペス、ヘルペス性歯肉口内炎、角膜ヘルペスなどを起こすのは、単純ヘルペスウイルス1型。単純ヘルペスウイルス2型は性器ヘルペスなどを引き起こします。水ぼうそうや帯状疱疹を引き起こすものは、水痘・帯状疱疹ウイルスと呼ばれます。 このように、ひとくちに「ヘルペス」といってもその種類はさまざまであるため、水ぼうそうのワクチンは、水痘・帯状疱疹ウイルスには有効ですが、ほかのヘルペスウイルスには効き目がありません。 単純ヘルペスウイルスを防ぐためのワクチンは、2016年現在、開発段階にあり、残念ながらまだ実用化はされていません。このため、予防接種による口唇ヘルペスや性器ヘルペスの予防はできませんが、発症後に抗ヘルペスウイルス薬による治療を行うことが可能です。ヘルペスは、適切な処置をするのが早いほど、症状が軽く済み回復も早い病気です。ヘルペスが疑われるような症状が現れた場合は、早めに病院へ行きましょう。 また、ヘルペスは感染症であるため、ほかの人にうつしてしまう可能性もあります。患部を触った手でほかの人や、自分の体のほかの部分に触ったりしないように注意しましょう。 ■関連記事 要注意!新生児のヘルペス もしヘルペスにかかったらどうしよう? 原因は、症状は?ヘルペスはこんな病気 公開日:2016/03/14

子供っていろんなところから病気をもらってきてしまいますよね。高熱を出して苦しそうにしていたりすると、心配になってしまいます。病気になってから治療するのは、親も子供も大変。ぜひ予防をして、子供を病気から守ってあげましょう。 目次 予防で子供を病気から守ろう! 病原体の侵入を防ぎ、健康な体を保つ 予防接種のタイミング 予防で子供を病気から守ろう! 子供っていろんなところから病気をもらってきてしまいますよね。高熱を出して苦しそうにしていたりすると、心配になってしまいます。病気になってから治療するのは、親も子供も大変。ぜひ予防をして、子供を病気から守ってあげましょう。 ここでは、子供の病気の予防方法についてご紹介します。毎日の生活の中でできる簡単な予防方法から、病院で受ける予防接種まで、知識を身につけておきましょう。 病原体の侵入を防ぎ、健康な体を保つ 子供の病気の中で多いのは、病原体に感染して発症する感染症。いわゆる「病気をもらってくる」状態です。感染症は、病原体が体内に入り込み、その体の状態によって発症するものです。反対にいえば、「病原体を体の中に入れない」、「体の状態をよくして発症を防ぐ」ことで、感染症は防ぐことができるということです。 感染症の原因となる病原体は、ウイルスと細菌です。このウイルスと細菌が体の中に入り込むには、飛沫感染、空気感染、接触感染、経口感染といった経路があります。このため、まずこの感染経路を絶つことが予防の大切な一歩となるわけです。 感染経路を絶つ方法のひとつが「手を洗うこと」。とても簡単なことのようですが、しっかりとできれば効果も高まります。 子供に「手を洗ってきなさい」といっても、あっと言う間に戻ってきて「本当に洗ったのかな?」なんていうことありませんか?これでは効果も半減。薬用せっけんや消毒薬で、手のひら、甲、指の間、指先、手首までをしっかりと洗うように、教えてあげましょう。 また、飛沫感染や空気感染を防ぐにはマスクやうがいも有効です。 そして、もし病原体が体の中に入ってしまっても、体に抵抗力があれば発症を防ぐことができます。抵抗力をつけるためには、普段から規則正しい生活を送る、適切な運動をする、といったことの他に、予防接種を受ける、という方法があります。 それでは、次にこの予防接種についてご紹介しましょう。 予防接種のタイミング 予防接種は、これを受けることで子供を病気から守ることができる大切な手段で、法律に基づいて市町村が実施する定期予防接種と、保護者が選択して受ける任意接種があります。 予防接種には、ヒブ、四種混合、BCG、MR、ロタウイルス、インフルエンザなど多くの種類があり、それぞれ接種する回数なども違います。予防接種のスケジュールをかかりつけ医と相談しておくと、接種のタイミングを逃すこともないですね。 また、予防接種を受けるときは子供の体調に注意をしましょう。体調が悪いときには予定していたタイミングでも無理をせず、次の機会に受けるようにしましょう。少しでも心配に思うことがあれば、医師に相談してくださいね。 公開日:2016/02/29

ヘルペスの原因となる単純ヘルペスウイルスが引き起こす「単純ヘルペス脳炎」という病気は、重篤な症状を示すことがあり、注意が必要な病気です。単純ヘルペス脳炎とはなんでしょうか?その原因や症状についてご紹介しましょう。 目次 迅速な対応が大切! 新生児期の単純ヘルペス脳炎について 成人の単純ヘルペス脳炎について 迅速な対応が大切! 「ヘルペス」というと、口の周りにできる「口唇ヘルペス」や、性器周辺にできる「性器ヘルペス」などが一般的に挙げられます。症状としては、患部の皮膚の湿疹や水ぶくれといったものがありますが、適切な治療を行えば1週間程度で治るものです。しかし、このヘルペスの原因となる単純ヘルペスウイルスが引き起こす「単純ヘルペス脳炎」という病気は、重篤な症状を示すことがあり、注意が必要な病気です。日本では年間に約350人が発症するといわれていて、場合によっては高度後遺症を残したり、亡くなったりすることもある病気です。 単純ヘルペスウイルス1型、または2型の初期感染時、または再活性時に発生するもので、新生児ヘルペス脳炎と、小児期・成人のヘルペス脳炎ではその病態が異なります。以前はこの病気にかかると、6~7割の患者さんが亡くなっていましたが、現在では抗ヘルペスウイルス薬が開発され、早期に治療ができるかどうかが重要なポイントとなっています。 この単純ヘルペス脳炎とは?その原因や症状について、新生児期のものと、成人のものにわけてご紹介しましょう。 新生児期の単純ヘルペス脳炎について 新生児ヘルペス脳炎は、母親の性器ヘルペスから産道感染することが最も多いといわれています。 症状としては、発熱や哺乳力の低下、活気がないといったものがみられ、その後、痙攣、肝機能異常、呼吸障害、出血傾向が認められるようになります。治療には、一刻も早い抗ウイルス剤の投与が必要で、投与のタイミングが予後を大きく左右します。このため、ヘルペス脳炎が疑われた時点で(確定していなくても)、治療が開始されます。 抗ウイルス剤の開発により、以前と比べて致命率は減少しましたが、運動麻痺や知的障害、てんかんなどの後遺症をもたらす場合もあるため、治療後も医師による十分な経過観察が必要です。 成人の単純ヘルペス脳炎について 新生児や小児期のヘルペス脳炎がヘルペスウイルスへの初期感染に伴って発症することが多いのに対して、成人の場合はほとんどがウイルスの再活性化によるものです。 急性期の症状としては、発熱や頭痛、嘔吐、意識障害、痙攣、記憶障害、言語障害、人格変化、異常行動、脳神経症状など様々なものがあります。早期治療の重要性は新生児期の場合と同様で、中枢神経症状がみられた場合は、まずヘルペス脳炎を念頭に置いた診断、治療が必要とされています。 公開日:2016/03/07

子供の多く集まる保育所では、感染症などの病気をいかに防ぐかが大きな課題となります。保育所内での感染対策、保護者との情報共有の二つの観点から、感染症対策について解説します。 目次 感染対策と情報共有 保育所内での感染対策 保護者との情報の共有 感染対策と情報共有 子供の多く集まる保育所では、感染症などの病気をいかに防ぐか、ということが大きな課題となります。感染症を防ぐためには、保育所内での感染対策、親御さんたちとの情報共有が不可欠です。 ここでは、保育所内での感染対策、保護者との情報共有の二つの観点から、感染症対策について考えてみましょう。 保育所内での感染対策 感染症の三大要因は、「感染源」「感染経路」「感受性」といわれています。 「感染源」は、病気にかかっている子供の排泄物や飛沫、食品の細菌やウイルス、動物が保有する細菌などが考えられます。病気にかかっていることが明らかな子供の場合は、保育所に来ることを控えてもらう、また、保育所で発症した場合には医務室などの、ほかの子供とは離れた場所で休養させる、といった対応が必要でしょう。 また、病気に感染していても症状が現れない場合もあります。これは、子供に比べて体力のある職員にもあてはまります。このようなことを考慮して、感染症の流行期間中は、お互いに感染経路対策に気を配ることが大切です。 では、感染経路対策とはどのようなものでしょうか。感染経路には主に、「飛沫感染」「空気感染」「接触感染」「経口感染」が考えられます。 「飛沫感染」や「空気感染」を最小限にとどめる方法として、「咳エチケット」が挙げられます。これは、咳やくしゃみを人に向けて発しない、咳が出るときはマスクをする、ハンカチやタオル、手などで口を覆う、といったものです。 「接触感染」への有効な対策は、「手をよく洗うこと」。簡単なことのようですが、子供の場合、面倒くさがって手を洗わない、洗っても十分に洗えていないという場合もあります。子供に手を洗うことの大切さ、正しい手洗いの方法を十分に教えることが重要です。この時、タオルの共有は絶対にしないようにしましょう。 また、ノロウイルスなどの感染経路となる経口感染を防ぐためには、食材の適切な管理や、調理器具の洗浄や消毒とともに、調理従事者の手指の衛生管理や体調管理も不可欠となります。 最後に「感受性」についてです。「感受性」とは、その人が病原体に感染して感染症を発症することをいいます。感受性対策とは、病原体に感染しても発症しないようにすること、すなわち、あらかじめ免疫を得るようにすることです。この方法として有効なのが予防接種です。この予防接種の重要性を保護者に理解してもらい、年齢に応じて計画的に接種を受けてもらうように説明しましょう。 保護者との情報の共有 保育所での感染を防ぐためには、保育所内での対策だけではなく、保護者と十分に情報を共有し理解を得ることも大切です。 保育所内で感染症が流行しているときは、保護者にもそのことを伝え、家庭でも手洗いや体調管理など、普段以上に気を配ってもらうようにしましょう。 また、子供が感染症にかかった場合は、本人の体調回復と同時に、周囲への感染拡大防止の観点から、病気の間は保育所を休んでもらうことになります。このような場合、病気が治って保育所に来るときには、医師の診断書を提出してもらうようにするなどの配慮が必要となるでしょう。 公開日:2016/03/14

2016年に、中南米を中心に流行が起きたジカ熱(ジカウイルス感染症)。心配される「小頭症」との関連や日本での感染に注意すべきことを解説します。 目次 蚊を媒介して感染する病気で、治療法も予防ワクチンもまだない状態 「小頭症」とジカ熱との関連は? 日本で流行する見込みは少なくても、蚊に刺されないよう気をつけるのは大切 蚊を媒介して感染する病気で、治療法も予防ワクチンもまだない状態 2016年に、中南米を中心に流行が起きたジカ熱(ジカウイルス感染症)。WHO(世界保健機関)は2月に、ジカ熱の流行を「国際的に懸念される公衆衛生上の緊急事態」にあたると宣言しました。これは、2014年に西アフリカを中心に起きて多くの死者を出した、エボラ出血熱の流行と同じレベルにあたります。海外で感染して、日本に帰国後ジカ熱と診断された人が発見されたと報道され、国内でも不安が広がりました。 ジカ熱は、ジカウイルスによって引き起こされる感染症です。ジカウイルスという名前は、アフリカのウガンダにある、ジカ森林のサルから初めて発見されたことに由来します。性行為や輸血での感染例はありますが、基本的には2014年に日本で流行したデング熱と同様に、ネッタイシマカとヒトスジシマカという蚊に刺されることによって感染します。 ジカ熱の主な症状 軽度の発熱 発疹 結膜炎 筋肉痛 関節痛 倦怠感 頭痛 …など ジカウイルスの感染後、2~12日の潜伏期間を経て発症すると、右記のような症状が2~7日続きます。また、全身の力が入らなくなる「ギラン・バレー症候群」を合併することもあります。ただし、発症することのほうが少なく、感染しても無症状の人や、程度が軽いため症状に気づかない人が8割を占めます。 ジカ熱の治療薬は見つかっていないため、症状が現れた場合はそれぞれの症状を抑える対症療法が行われます。また、予防ワクチンもまだ開発されていません。 「小頭症」とジカ熱との関連は? あまり重症化せず、エボラ出血熱のように命に関わるほどではないジカ熱が大きな問題となっているのは、子供の生まれつきの病気である「小頭症」との関連が示唆されているためです。小頭症は、生まれてきた赤ちゃんの頭蓋骨が正常なサイズよりも小さく、脳の発達の遅れにより知的障害などが引き起こされる恐れのある病気で、治療法はまだありません。ジカ熱が流行してからブラジルで小頭症が急増したのとともに、小頭症の赤ちゃんの血液や出産後の母親の羊水からジカウイルスが検出されました。そのため、ジカウイルスに感染した妊婦本人は無症状であっても母子感染(垂直感染)が起き、小頭症の子供が生まれてくる可能性が議論されているのです。 日本で流行する見込みは少なくても、蚊に刺されないよう気をつけるのは大切 ジカ熱の予防ワクチンはまだ開発されていないため、予防するうえで重要となるのは、流行している地域への渡航を控えることです。特に、まだ調査中ではありますが、赤ちゃんの小頭症との関連が示唆されているため、妊婦は渡航を避けたほうが良いと考えられます。しかし、2016年の8~9月には、流行地であるブラジルのリオデジャネイロでオリンピックとパラリンピックが開催されるため、多くの人々が渡航し、そして帰国することが予想されます。この時期は、日本が夏なのに対してブラジルは冬ですが、亜熱帯では冬でも平均気温が20度以上なので、ジカウイルスを媒介する蚊は活動していると考えられます。 流行地への渡航時はもちろん感染者が帰国した場合に備えて、長そで・長ズボンの着用や虫よけスプレーなどでできるだけ蚊に刺されないようにすることは、予防のために有効です。また、帰国後にジカ熱が疑われる症状が現れたり、不安に感じたりしたときは、できるだけ早く医療機関や保健所を訪ねて、血液検査や尿検査などを受けましょう。その際に、どの国に滞在していたのかを伝えることも大切です。 日本国内で、南米のようにジカ熱が流行する可能性は低いとみられています。しかし、蚊に刺されないように気をつけるのは、同じ蚊を媒介とする感染症の予防にもなるので、予防意識を高くもって行動するのは、健康維持のためには大切なことだと言えるでしょう。 公開日:2016/03/14

乳幼児を持つお母さんは特に注意!風邪とよく似た症状がでるRSウイルス感染症は、重症化すると命に関わる恐れがあります。RSウイルスの基礎知識と予防法、対処法について解説します。 目次 ただの風邪かと思いきや、肺炎などが引き起こされることも… RSウイルスの主な症状 重症化しやすいのは、初めて感染する生後数週間から数ヵ月まで ワクチンはないため、予防にはRSウイルスとの接触を避けることが大切 ただの風邪かと思いきや、肺炎などが引き起こされることも… 小さな子供が風邪をひくと、親としてはとても心配ですが、数日で治ると分かっている点で、少しは安心できるのではないでしょうか。ただし、それが風邪とよく似た病気「RSウイルス感染症」であれば、話は別です。 RSウイルス感染症は、RSウイルス(Respiratory Syncytial Virus:呼吸器合胞体ウイルス)の感染が原因で起きる、乳幼児に流行する感染症の一つです。通常は発熱や咳など、風邪と同じような軽い症状が出ますが、重症化したり、重い合併症が現れたりすると、命に関わる恐れがあります。 流行のピークとなるのは冬ですが、7月頃からかかる子供が増え始め、8月の終わりから9月の初め頃の、秋を迎える時期に流行することもあります。RSウイルスは感染力が強く、1歳までに半数の子供が、そして2歳までにはほぼ全員が、一度は感染すると言われています。大人がかかることもありますが、ほとんどの場合は風邪と同様の、軽い症状しか出ません。 RSウイルスの主な症状 【軽い症状】 熱が出る 鼻水が出る 咳が出る 【悪化した場合の症状】 喘鳴(ぜんめい:ゼーゼーという呼吸音が聞こえる状態)がみられる 呼吸困難になる 呼吸が速くなる 【重い症状】 細気管支炎 肺炎 …など ※突然死の恐れがある無呼吸発作や、意識障害やけいれんを起こす急性脳症などの、重い合併症が現れることもあります。 重症化しやすいのは、初めて感染する生後数週間から数ヵ月まで RSウイルスに初めて感染した子供の約7割は、鼻水などの軽い症状が出るだけですが、約3割は咳が悪化し、喘鳴(ぜんめい)や呼吸困難症状などが現れます。RSウイルス感染症は、何度も繰り返しかかることがある病気ですが、もっとも症状が重くなりやすいのは、初めてかかったときだと言われています。生後数週間から数ヵ月までの早期の乳児期は、細気管支炎や肺炎などの重い症状が引き起こされやすいので、早めに医師に診てもらいましょう。また、早産による低体重、心臓や肺の病気がある、神経や筋肉の病気がある、免疫機能が生まれつき正常に働かないというような子供も、重症化の危険性が高くなります。 RSウイルス感染症にかかった場合は、それぞれの症状を抑える薬による治療が行われます。実際はRSウイルスに感染していながら、風邪の治療だけを続けている場合は重症化の恐れがあるため、心配であればRSウイルスの検査をしてもらえるよう、医師に申し出ましょう。 ワクチンはないため、予防にはRSウイルスとの接触を避けることが大切 RSウイルスに対するワクチンはないので、予防するには、RSウイルスと子供を接触させないことが大切です。RSウイルスは、感染した子供の咳やくしゃみのしぶきを吸い込んだり、RSウイルスがついた手指や器具と接触したりすることで感染が広まります。そのため、感染した子供や、その子供が使った食器やおもちゃとの接触を避けることは、予防に有効です。ただし、まわりの子供や器具が感染しているか見た目では分からないため、日頃からアルコールや消毒液による身の回りのものの消毒、流水と石鹸による手洗い、赤ちゃん用マスクを付けられる1歳半以上であれば、マスクの着用などをこころがけることも大切です。 早産であることや、呼吸器や心臓の特定の病気があることなど、RSウイルスに感染した後の重症化リスクが高い場合は、パリビズマブという重症化を防ぐ薬の投与の対象となります。流行が始まる秋を迎える時期から、まだRSウイルスに感染していないうちに、月1回注射します。投与の対象となる条件など、詳しくは医師に問い合わせましょう。 RSウイルス感染症は、一般的には医師が書く「登園許可証明書」を幼稚園や保育園に提出する必要がない病気とされています。そのため、症状が治まったと判断されれば、幼稚園や保育園に通っても問題ないと考えられます。ただし、自治体および幼稚園・保育園によっては、保護者が記入した「登園届」の提出が求められることや、登園可能な回復状態の目安が設けられていることがあります。詳しくは、幼稚園や保育園に直接問い合わせてみましょう。 ■関連記事 インフルエンザを正しく理解しよう!都市伝説に惑わされないために 公開日:2015/10/05

ヘルパンギーナは、手足口病やプール熱と並ぶ代表的な夏風邪で、5歳以下の子供でよくみられる感染症です。ヘルパンギーナの感染経路や予防法、かかってしまったときの対処法をご紹介します。 目次 発熱と、口の内側にできる水疱、のどの痛みが主な症状 咳やくしゃみを介した飛沫感染や、手指を介した接触感染で広まる 予防で大切なのは、なんといっても手洗い・うがい・咳エチケット 発熱と、口の内側にできる水疱、のどの痛みが主な症状 風邪の季節といえば冬ですが、意外と多いのが夏の風邪。手足口病やプール熱と並ぶ代表的な夏風邪に、ヘルパンギーナがあります。ヘルパンギーナは、初夏から秋にかけて、5歳以下の子供でよくみられる感染症です。その病名は、ヘルペス(水疱)とアンギーナ(急性扁桃炎:のどの炎症)を意味するドイツ語に由来します。感染してから2~4日の潜伏期を経て、発症します。 ヘルパンギーナの主な症状 ●発熱 ●口内の水疱 ●倦怠感 ●食欲不振 ●嘔吐 ●手足の痛み ●咽頭痛(のどの痛み) ●咽頭(のど)の赤み …など 症状はまず高熱が現れますが、1~2日ほどで熱は下がります。それと前後して、名前の由来通りの特徴である、口の内側やのどの奥に1~5mmの水疱ができたり、咽頭痛(のどの痛み)が生じたりします。水疱が破れると、口の内側の痛みも生じます。乳幼児では、機嫌が悪くなる、食事やミルクを受け付けないという形で現れ、脱水症状を伴うこともあります。 原因ウイルスが脳に侵入して無菌性髄膜炎(細菌以外の原因による、脳を覆う膜の炎症)を、また心臓に侵入して心筋炎(心臓の筋肉の炎症)を引き起こし、発熱や嘔吐など、ヘルパンギーナと同様の症状が現れていることもまれにあります。 咳やくしゃみを介した飛沫感染や、手指を介した接触感染で広まる ヘルパンギーナを引き起こすのは主に、コクサッキーウイルスA群というグループに分類されるウイルスです。グループ内には複数の種類のウイルスが存在するため、一度かかって治っても、別の原因ウイルスによってまたかかることがあります。ヘルパンギーナは、かかった人の咳やくしゃみ、つばのしぶきなどを介する飛沫感染や、つばや鼻水が付いたおもちゃに触れた手指を介する接触感染、口の粘膜を介する経口感染などによって広まります。 ヘルパンギーナの原因ウイルスに効果を発揮する抗ウイルス剤は、まだありません。そのため、治療はこまめな水分補給や解熱剤の使用、のどの痛みを抑える薬の使用など、それぞれの症状に応じた対症療法が行われます。子供が飲食を嫌がる場合は、そうめん、ゼリー、プリンなどの、のどごしのよいものを用意してあげるとよいでしょう。症状が治まっても数週間は便にウイルスが存在するので、ヘルパンギーナにかかった子供がウンチをしたときのオムツ替えなど、便を扱う際は、使い捨て手袋を用いるとよいでしょう。 通常、症状は2~4日で自然に治まります。ただし、無菌性髄膜炎や心筋炎を合併している場合は、入院が必要になることがあります。 熱が下がってから1日以上が経ち、普段どおりの食事ができるようになったら、一般的に幼稚園や保育園に通っても問題ないと考えられます。登園許可が必要か、プールに入っても良いかなど、詳しいことは通っている幼稚園や保育園に問い合わせましょう。 予防で大切なのは、なんといっても手洗い・うがい・咳エチケット ヘルパンギーナには、ワクチンがありません。そのため、予防するには一般的な風邪と同様に、手洗い・うがいをしっかりと行い、咳やくしゃみが出るときはマスクを着用する「咳エチケット」が効果的です。接触感染を防ぐために、おもちゃの貸し借りにも注意が必要です。 なお、子供に多い病気ではありますが、大人がヘルパンギーナにかかることもあります。大人も、ヘルパンギーナにかかった子供と接するときなどは特に、油断せず風邪予防に努めましょう。 ■関連記事 大人も子供も要注意!「夏に流行る感染症」 海外旅行の怖いお土産 感染症で下痢・嘔吐 公開日:2015/07/21

2015年5月以降に韓国で大流行が報じられた中東呼吸器症候群(MERS:マーズ)は、MERSコロナウイルスに感染して発症し、発熱や咳などの症状が引き起こされます。MERSの感染経路や、MERSが疑われる際の対応方法などを解説します。 目次 基礎疾患(持病)がある人の致死率は約40% 日本にいるヒトコブラクダは大丈夫?フタコブラクダは? MERSかも…と思ったときは、病院ではなく保健所に連絡を! 基礎疾患(持病)がある人の致死率は約40% 2015年5月以降に、韓国での死者30人以上、感染者180人以上の流行が報じられた中東呼吸器症候群(MERS:マーズ)は、その名の通り、主に中東地域(※後述)で2012年から報告されてきた感染症です。MERSコロナウイルスに感染して発症し、右記のような症状が引き起こされます。2003年に中国や香港を中心に流行した重症急性呼吸器症候群(SARS:サーズ)の原因となったウイルスも、同じくコロナウイルスという種類でしたが、SARSとMERSは別の病気です。 MERSの主な症状 ●発熱 ●咳 ●息切れ ●下痢などの消化器症状 …など MERSコロナウイルスの潜伏期間は、最長で14日間です。感染しても、必ずしも症状が現れるとは限らず、症状が出たとしても軽症の場合もあります。ただし、高齢者や糖尿病、慢性肺疾患、免疫不全などの基礎疾患(持病)がある人は重症化しやすく、約40%の確率で死に至ります。MERSの死亡例の約90%が、このような基礎疾患にかかっている人たちだと報告されています。 ※中東地域:アラブ首長国連邦、イエメン、イラン、オマーン、カタール、クウェート、サウジアラビア、ヨルダン、レバノン(2015年6月24日現在) 日本にいるヒトコブラクダは大丈夫?フタコブラクダは? ヒトコブラクダが、MERSウイルスの保有動物だと考えられています。2015年の韓国でのMERSの流行の際に、日本国内にいる25頭前後のヒトコブラクダを検査したところ、MERSコロナウイルスは検出されませんでした。なお、フタコブラクダでは、これまでMERSウイルスが検出されたことはありません。 ヒトコブラクダに直接接触しなくても、MERSは人から人へと感染します。主な感染ルートは、感染した人の咳やくしゃみなどのしぶきを介する飛沫感染や、感染した人との接触による接触感染です。韓国での流行の経緯ははっきりとはわかっていませんが、病院内で人から人へと感染した院内感染だと言われています。ただし、同じく飛沫感染をする季節性インフルエンザほどは感染力が強くないため、MERSが人から人へ次々と感染することはありません。 MERSかも…と思ったときは、病院ではなく保健所に連絡を! MERSが日本で流行する可能性は低いと言われていますが、万が一発症した場合は、症状に応じた対症療法が行われます。 MERSに対するワクチンはないため、予防するにはMERSコロナウイルスに感染しないように、特に重症化しやすい基礎疾患がある人は、流行している地域にはできるだけ行かないようにしましょう。やむをえず流行地域へ行くことになった場合、現地では手洗い・うがい・マスクの装着などを心がけましょう。MERSに限らず、ほかの感染症の予防にもなります。 なお、流行地域からの帰国後にMERSが疑われる症状が現れた際は、潜伏期間である14日がまだ経っていない場合、医療機関を受診してはいけません。これは、その場にいる医療従事者や、受診に来ていた人たちに感染してしまう恐れがあるからです。必ず最寄りの保健所に電話で連絡をして、指示を仰ぐようにしましょう。 公開日:2015/07/06

2014年に日本では69年ぶりに感染が確認されたデング熱はデングウイルスに感染したヒトスジシマカなどを介して感染する病気です。デング熱に感染した場合の対処法や予防法についてご紹介します。 目次 高熱や全身の痛みなどが、デング熱の初期症状 市販の解熱鎮痛剤で、デング熱の症状が悪化する!? 蚊に刺されにくい服装で、虫よけスプレーなどを利用しよう! 高熱や全身の痛みなどが、デング熱の初期症状 2014年に東京の代々木公園を中心として、8月以降に160名の感染が確認されたデング熱。主な流行地域は東南アジア・南アジア・中南米などとされていて、国内で流行したのは実に69年ぶりです。2013年8月に日本を訪れたドイツ人旅行者が、帰国後に発症したことで日本での感染が疑われ、注意が呼びかけられていましたが、多くの日本人にとっては聞き慣れない病気でした。 デング熱は、デングウイルスに感染したヒトスジシマカ(ヤブカ)や、海外にいるネッタイシマカという種類の蚊のメスに刺されてかかる感染症です。一般的に家の中にいるアカイエカいう種類に刺されても感染はせず、また人から人へ感染することもありません。 感染してから2~15日、多くの場合は3~7日で現れるのが、下記の初期症状です。体内のウイルスは1週間ほどで消失し、それに伴い症状も治まります。ただし、重症化してショック状態になると、最悪の場合は命に関わることもあります。重症のデング熱が疑われる場合は、採血による検査が行われます。 デング熱の主な症状 【初期症状】 ●高熱 ●頭痛 ●赤い発疹 ●嘔吐 ●下痢 ●目の奥の痛み ●背中の痛み ●全身の筋肉痛・関節痛 【重症】 ●出血(歯茎からの出血・血便・血尿など)によるショック状態 …など デング熱患者の赤い発疹 市販の解熱鎮痛剤で、デング熱の症状が悪化する!? デング熱を根本から治すような治療法は、まだありません。そのため、点滴による水分・栄養の補給や、高熱や痛みがある場合は解熱鎮痛剤などで、症状を抑える対症療法が行われます。ただし、市販の解熱鎮痛剤を服用すると、薬の種類によってはかえってデング熱の症状を悪化させてしまうことがあります。自己判断はせず、医師に相談しましょう。 感染症の中には一度かかると免疫ができて、その後は二度とかからないものがありますが、デング熱には当てはまりません。デングウイルスには複数の型があり、一度かかるとその原因となった型のウイルスには感染しなくなりますが、他の型による感染は起きます。むしろ、二度目以降の感染は重症になりやすいと言われています。 蚊に刺されにくい服装で、虫よけスプレーなどを利用しよう! デング熱のワクチンは開発中ですが、まだ実用化のめどはたっていません。そのためデング熱を予防するには、デングウイルスに感染している蚊に、できるだけ刺されないように注意するしかありません。 デングウイルスを媒介するヒトスジシマカは、夏場の日中に、屋外の草むらなどで活動します。そのため外出する際は、長そでや長ズボンで肌の露出を少なくし、虫よけスプレーや蚊取り線香、殺虫剤などを利用するのが有効です。色の濃いものに近づくという習性が蚊にはあるので、白色などの薄い色の洋服を身につけると、なお良いでしょう。 なお、蚊を手でたたきつぶすことはよくありますが、それによってデング熱に感染することはなく、水で洗い流せば何も問題はありません。 ヒトスジシマカの発生を防ぐのも、デング熱を予防するためには大切なことです。ヒトスジシマカは、水たまりに卵を産むため、水たまりをなくすことで、発生を防げます。特に、以下のような水たまりができやすいところは、特に注意が必要です。 ヒトスジシマカの成虫は気温が下がる秋には死んでしまうのに対して、卵は冬を越すことができます。季節を問わず、できるだけ水たまりができないように気をつけましょう。 水たまりができやすいところ ●植木鉢の下に敷く皿 ●排水溝 ●屋外に放置された水がたまりやすいもの (子供のおもちゃ、じょうろ、空きビン・空き缶・ペットボトル、古タイヤ) …など 公開日:2015/06/08

肺炎球菌ワクチンの接種は、子どもの健康に大きく関わる、大切なものです。子育てで大変な時期ではありますが、子どものためにも必ず受けるようにしましょう。 目次 恐ろしい感染症から子どもを守る、小児用肺炎球菌ワクチン 1~3回目と接種の間隔が違う!4回目の接種(追加接種)は注意が必要 標準的なスケジュールから外れても接種は可能 恐ろしい感染症から子どもを守る、小児用肺炎球菌ワクチン 子どもは生後2ヵ月以降から、小児用肺炎球菌ワクチンによる予防接種を開始することが推奨されています。日本で2013年11月以降から用いられているのは「13価小児用肺炎球菌ワクチン」で、世界の120ヵ国以上で承認されています。米国、英国、ドイツ、フランスなどをはじめとする74ヵ国では定期接種ワクチンとして導入され、効果・安全性ともに確かめられています。 このワクチンの接種では、細菌性の肺炎や中耳炎のほかに、以下のような全身に影響を及ぼす病気を予防することができます。 ●細菌性髄膜炎 脳や脊髄を覆う髄膜の奥まで菌が侵入して、炎症を起こす病気です。急な発熱、嘔吐、食べない・飲まない、意識がもうろうとする、ぐったりとするという症状のほかに、重い後遺症が残ることや、最悪の場合は命に関わることがあります。ワクチンが普及する前の日本では、毎年約200人の子どもがこの病気にかかり、そのうちの約3分の1が命を落としたり、重い障害が残ったりしました。 ●菌血症 血液中に菌が侵入した状態です。治療せず放置すると、さまざまな臓器に菌がうつり、前述の髄膜炎や後述の敗血症など、重い病気が引き起こされることがあります。ワクチンが普及する前の日本では、毎年約18,000人の子どもがこの病気にかかっていたと言われています。 ●敗血症 血液中に侵入した菌によって、全身症状が現れる病気です。発熱、低体温、心拍数の増加、呼吸数の増加や、血圧の低下によるショック状態などがみられ、最悪の場合は命に関わることがあります。 ワクチンの接種では、副反応が出ることもあります。主な副反応は発熱、注射部位の腫れ・赤みなどで、まれにショック状態やアナフィラキシー様反応(呼吸困難や全身性のじんましんなどを伴う重いアレルギー反応)などが報告されています。特に注意が必要なのは、接種後30分以内。病院内にとどまって様子をみるか、病院の外でも医師とすぐに連絡がとれる場所にいれば、安心できるでしょう。 なお、小児用肺炎球菌ワクチンは不活化ワクチンという種類です。これを接種したせいで、肺炎球菌による病気の症状が出るということは起きません。 1~3回目と接種の間隔が違う!4回目の接種(追加接種)は注意が必要 0歳代(生後2~11ヵ月齢)で1~3回目の接種を受け、1歳代(12~15ヵ月齢)で4回目の接種(追加接種)を受けるのが、小児用肺炎球菌ワクチンの標準的な接種スケジュールです。1~3回目の接種が初回免疫(基礎免疫)と呼ばれるのに対して、4回目の接種は追加免疫と呼ばれ、十分な免疫力を子どもにつけさせるために、特に大切です。 ここで注意が必要なのが、接種のタイミング。1回目と2回目、また2回目と3回目の間隔は、27日間以上あけてから次の接種を行うことになっています。ところが3回目から4回目だけは、あける間隔が60日間以上。ここだけ間隔が長くなるため、つい忘れてしまい、気づけば15ヵ月齢を過ぎていた、ということが起こりやすくなります。 小児用肺炎球菌ワクチンの標準的な接種スケジュール 4回目の接種を忘れないためには、よく目にするカレンダーに印をつけたり、小児が受けるべき予防接種のスケジュールがまとめられた専用のスケジュール表を使用したりするのがおすすめです。このスケジュール表は、国立感染症研究所のサイトなどで入手できます。接種の時期が近づくと、携帯電話のメールやハガキで知らせてくれるサービスを利用するのも良いでしょう。 標準的なスケジュールから外れても接種は可能 接種対象月年齢と接種回数 接種開始の月齢・年齢接種回数 2~6ヵ月齢(標準)4回 7~12ヵ月齢3回 12~24ヵ月齢2回 24ヵ月齢~6歳未満1回 ※定期接種の対象は5歳未満まで 接種の時期を忘れていなくても、子どもの体調や家庭の事情により、4回目に限らず、小児用肺炎球菌ワクチンの接種を受けられないこともあるでしょう。しかし、たとえ標準的なスケジュールどおりに接種を受けられなかったとしても、すぐに諦める必要はありません。接種開始の月齢・年齢によっては、標準スケジュールどおりではないものの、接種が可能な場合があります。 肺炎球菌ワクチンの接種は、子どもの将来の健康に大きく関わる、とても大切なものです。ほかの種類の予防接種と、同時に受けられる場合もあります。子育ての中でも大変な時期ではありますが、子どものためにも遠慮することなく医師に相談して、必ず受けるようにしましょう。 公開日:2015/03/16

日本人の死因の第3位である肺炎の予防には、肺炎球菌ワクチンの接種が有効です。65歳以上の方は、自治体が行う定期接種の対象となります。平成26年度の定期接種の対象者一覧を紹介するとともに、肺炎予防のために日頃から気をつけたいことを詳しく解説します。 目次 日本人の死因の第3位!65歳以上の方は肺炎予防を 65歳未満の人や、以前に接種したことがある方も接種が可能 日頃からの予防も大切 65歳以上のご家族がいる方へ 日本人の死因の第3位!65歳以上の方は肺炎予防を がんと心臓の病気は、それぞれ日本人の死因の第1位と第2位にあたる恐ろしい病気として広く知られ、メディアでも注意が呼びかけられています。しかし、「それらに次ぐ第3位は?」と聞かれて、正しく答えられる人はどれくらいいるでしょうか。日本人の死因の第3位は、肺炎です。肺炎は、気候や体調の変化、持病の悪化などがきっかけとなり、季節を問わずかかる可能性のある病気で、抗生物質による治療が行われます。発熱、咳、痰、息切れ、胸の痛みなどがみられますが、症状が現れないことや、風邪だと思い込んでしまうことにより、治療が遅れるケースもあります。高齢になると重症化するリスクが高まるため、65歳以上の方は特に注意が必要です。 肺炎の予防には、肺炎球菌ワクチンの接種が有効です。2014年(平成26年)10月1日から、肺炎球菌ワクチンは自治体が行う定期接種の対象となりました。対象年齢に該当する、過去にこのワクチンを接種したことがない方は、平成30年度までの間に1人1回、ワクチン接種の公費助成を受けられます。 平成27年度(平成27年4月1日から平成28年3月31日まで)の対象となるのは、以下の条件を満たす方です。 肺炎球菌ワクチン定期接種の対象者 平成30年度(平成30年4月1日から平成31年3月31日まで)は以下の(1)もしくは(2)の方が定期接種の対象です。 ■対象者(1)生年月日 対象者生年月日 65歳となる方昭和28年4月2日生~昭和29年4月1日生 70歳となる方昭和23年4月2日生~昭和24年4月1日生 75歳となる方昭和18年4月2日生~昭和19年4月1日生 80歳となる方昭和13年4月2日生~昭和14年4月1日生 85歳となる方昭和 8年4月2日生~昭和 9年4月1日生 90歳となる方昭和 3年4月2日生~昭和 4年4月1日生 95歳となる方大正12年4月2日生~大正13年4月1日生 100歳となる方大正 7年4月2日生~大正 8年4月1日生 ■対象者(2) 0歳から65歳未満の方で、心臓、腎臓、呼吸器の機能に自己の身辺の日常生活活動が極度に制限される程度の障害やヒト免疫不全ウイルスによる免疫の機能に日常生活がほとんど不可能な程度の障害がある方 出典:「肺炎球菌感染症(高齢者)」厚生労働省 肺炎球菌ワクチンは、各自治体の指定する医療機関で接種できます。助成の有無や内容について、詳しくはお住まいの自治体に問い合わせましょう。ワクチンの接種後には、注射した部位の痛み・赤み・腫れや筋肉痛、だるさ、発熱、頭痛などの副反応が現れることがあります。これらが現れた場合は、医師に相談しましょう。 65歳未満の人や、以前に接種したことがある方も接種が可能 肺炎球菌ワクチンは定期接種の対象ではない方も、公費助成は受けられませんが、任意で接種することができます。心臓や呼吸器の病気や糖尿病、腎不全などの持病がある方は、肺炎のリスクが高いため、予防接種を受けることが勧められます。ただし、脾臓を摘出した人などを除いて自由診療にあたるため、健康保険の対象外となります。詳しくは、予防接種をしに行こうと考えている医療機関に問い合わせてください。 過去に接種したことがある場合も、2回目以降の接種は可能です。ただし、5年以内に再接種すると、注射した部位の痛みなどが強く現れる恐れがあるため、前回の接種から5年以上の間隔を空ける必要があります。一般的に、肺炎球菌ワクチンの予防効果は、5年以上持続すると考えられています。再接種を希望する場合は、回数やタイミングなどを医師に相談しましょう。 日頃からの予防も大切 風邪やインフルエンザは、免疫力が低下するとかかりやすくなることが知られていますが、それらにかかると免疫力はさらに低下します。それがきっかけとなり、肺炎を発症することがあります。また、飲み込んだ食べ物や飲み物、唾液などが誤って気管に入ってしまう誤嚥(ごえん)が起き、それらに含まれていた細菌によって、肺に炎症が引き起こされることもあります。こういった肺炎にかかる仕組みを理解して、ワクチンの接種以外に、日常生活では下記のようなことに注意し、予防を心がけましょう。 日頃からできる肺炎の予防方法 ●手洗い・うがいをする ●マスクを着用する ●持病を治療する ●禁煙する ●十分な睡眠時間の確保などにより、免疫力を高める ●ゆっくりと食事する ●歯磨きで口の中を清潔に保つ …など 65歳以上のご家族がいる方へ 肺炎は高齢になるほどリスクが高くなり、それに伴い入院や介護の負担も大きくなります。定期接種の対象者は年度ごとに異なり、自分がその年度の対象となっていることに、高齢者本人は気づいていない可能性があります。定期接種のタイミングを逃さないために、ご家族の方が気にかけて、予防接種をすることを本人に呼びかけてあげてください。 公開日:2015/05/11更新日:2018/06/25

2014年の3月以降、西アフリカ諸国でエボラ出血熱が流行し、WHOは緊急事態を宣言、死者は2,000人を超えました。日本ではあまり知られてこなかったこの感染症について、解説します。 目次 治療薬やワクチンがない、エボラウイルスによる感染症 空気感染はせず、血液や吐物を介した接触感染が主なルート 日本でただちに流行するリスクは低い。予防のために、流行地域への渡航は控えよう エボラ出血熱関連リンク集 治療薬やワクチンがない、エボラウイルスによる感染症 2014年の3月以降、西アフリカ諸国(ギニア・リベリア・シエラレオネ・ナイジェリア)で、エボラ出血熱の流行が起きました。WHO(世界保健機関)は2014年8月8日に、ついに緊急事態を宣言。死者は2,000人を超えました。日本ではあまり知られてこなかったこの感染症について、解説します。 Q. エボラ出血熱とは、どんな病気なのでしょうか? A. エボラウイルスによる、命に関わることもある感染症。症状が現れるまでの潜伏期は2~21日。 エボラ出血熱は、エボラウイルスによる感染症です。必ずしも出血や発熱が現れるわけではなく、エボラウイルス病(Ebola virus disease:EVD)、エボラウイルス疾患、エボラウイルス感染症などと呼ばれることもあります。ウイルスの名前は、アフリカの、最初に感染が確認された地域を流れるエボラ川に由来します。 エボラウイルスに感染してから症状が現れるまでの潜伏期は、2~21日(通常は7~10日)。その期間を経た後、突然の発熱、頭痛、倦怠感、筋肉痛、のどの痛みなどが起こり、次いで嘔吐、下痢、発疹、肝機能および腎機能の異常、胸の痛み、出血(吐血、下血)などの症状が現れます。エボラウイルスには5種類あり、致死率は病気の型によって異なります。WHOによると、2014年の流行における致死率は53%です。 Q. どんな治療が行われるのでしょうか? A. 治療薬や予防ワクチンはないため、隔離して対症療法を行い、免疫力による回復を補助。 エボラウイルスに有効な治療薬や、予防ワクチンはありません。感染者を隔離したうえで、症状に応じて点滴・抗生物質・鎮痛剤・栄養治療食・ビタミン剤などを用いる対症療法を行って、患者自身の免疫力による回復を助けます。 2014年の流行では緊急事態として、未承認薬の使用が検討されています。未承認薬とは、治療薬となる可能性はあるものの、実際の治療効果や、副作用などの安全性が十分に確かめられていないため、国から治療薬として認められていない薬を指します。 空気感染はせず、血液や吐物を介した接触感染が主なルート Q. どのように感染するのでしょうか? A. 体液や汚染された注射針との接触により感染。インフルエンザのような空気感染はしません。 エボラウイルスに感染し、症状が出ている患者の体液(血液、唾液、排泄物、尿、汗、分泌物、吐物など)や、その体液に汚染された注射針などに触れ、ウイルスが傷口や粘膜から侵入する接触感染で感染します。感染者と接する機会のある医師や看護師は、体液との接触を避けるために、防護服、手袋、ゴーグル、マスク、ブーツなどによる、肌の露出を防ぐ完全防備が必要です。 2014年の西アフリカでの流行では、エボラ出血熱に関して正しい知識をもっているはずの医師や看護師の感染が、あいついで報告されています。これは、ただでさえ暑い気候の中で、完全に密閉された動きにくい防護服を着込んでの連日の作業により、疲労の蓄積や集中力が途切れることで、ミスが起きやすくなったからだと言われています。具体的なミスとして、防護服や手袋の着脱の際に感染者の体液に接触したことや、注射針が誤って自分に刺さったことなどが挙げられます。 一般的に、感染していてもまだ症状が出ていない潜伏期の患者からは、感染しません。空気感染もしないため、インフルエンザのように、咳やくしゃみ程度での感染も起きません。実際に流行が起きたアフリカの地域では、エボラウイルスに感染した野生動物(コウモリ、サルなど)の死体や、その生肉に直接触れることでも感染すると考えられています。自然界で、エボラウイルスを体に宿す宿主はコウモリだと考えられていますが、はっきりしたことはまだ分かっていません。 Q. 2014年の流行は、どうして起きたのでしょうか? A.「西アフリカで初」「都市部での発生」「葬儀の風習」などの、複数の条件が関係しています。 2014年以前にエボラ出血熱が流行したのは、中央アフリカの、人の行き来が少ない地域でした。2014年の流行では、西アフリカ各国の政府や医療機関に、エボラ出血熱の知識や経験がなく、対処に慣れていないため、患者の隔離などが遅れたと言われています。また、都市部での流行だったため、人の行き来や交流が多く、人から人へと感染する機会が多かったことも影響しています。上下水道など、インフラが十分に整備されていないことも、要因の一つです。 さらに西アフリカでは、葬儀の参列者が遺体に直接触れて、その死を悼むという風習があります。感染者が亡くなってまだ間もない時期は、遺体にウイルスが潜んでいます。特に、エボラウイルスは死の直前に最も感染力が増すとされているため、遺体を触るのは、感染リスクが高い行為だと言えます。 2014年にエボラ出血熱が流行した西アフリカ諸国 日本でただちに流行するリスクは低い。予防のために、流行地域への渡航は控えよう Q. 日本では流行しないのでしょうか? A. 流行地域への渡航者が少ないことから、日本でただちに流行するリスクは低いと考えられています。 エボラ出血熱は、直接的な接触によって感染する病気であり、流行地域は日本人の渡航者が少ないアフリカに限られることから、日本での流行はまず起きないと考えられています。 2014年の流行では、感染した人が、ウイルスを海外から日本国内へ持ち込まないように、水際対策も行われています。国際線の空港の検疫所では、アフリカから帰国した人が発熱していないかをサーモグラフィで確認したり、ポスターの掲示で注意を呼びかけたりする対策がとられています。 エボラウイルスへの感染が疑われる人が見つかった場合は、感染症指定医療機関へ搬送されることになります。感染症指定医療機関としては、「特定感染症指定医療機関」として3施設、「第一種感染症指定医療機関」として44施設があります。(2014年4月1日現在) 検査の結果、感染していることが明らかになれば、患者は感染防御対策の施された病室で治療を受けます。エボラ出血熱は一類感染症に指定されているため、感染症法に基づき、治療は公費によって提供されます。 エボラ出血熱を予防するために大切なのは、流行地域への渡航を控えることです。日本で流行するリスクが低いと聞いても、どうしても不安な気持ちを拭いきれない方は、流行地域でも推奨されている、石鹸での手洗い、食材には必ず火を通してから食べること、気になる症状が現れたらすぐに医療機関で相談することなどを実践しましょう。たとえエボラ出血熱に感染する恐れがなかったとしても、これらはほかの感染症の予防としても有効なので、不安が余計にかき立てられない限りは、無駄にはならないと言えるでしょう。 感染症を過剰に恐れたり過信したりしないために、確かな情報をもとにした判断を! 感染症が流行すると、「○○地域に住む複数の友人が、感染者を目撃したと言っている」「日本にも感染者はいるが、政府が情報を隠しているらしい」といった情報を、TVやインターネット、雑誌、口コミなどで、見聞きする機会が増えます。それらの情報は必ずしも正しいとは言えず、間違っている可能性も多くあります。間違った情報の出所として考えられるのは、勘違いや憶測、冗談、イタズラ目的のウソなど。やみくもに恐れる、あるいは過信するのではなく、公的機関などが発信する情報をもとに、正しい知識で判断するよう心がけましょう。 2014年エボラ出血熱関連リンク集 ●エボラ出血熱関連の詳しい情報はこちら 厚生労働省:エボラ出血熱に関するQ&A 国立感染症研究所:エボラ出血熱 WHO(世界保健機関):Ebola response roadmap ●国 ・地域別の渡航情報 (危険情報、スポット情報、広域情報等)はこちら 外務省:海外安全ホームページ 公開日:2014/09/16

ノロウイルスによる感染性胃腸炎は、風邪やインフルエンザと並んで冬に流行する病気。子供や高齢者は重症化しやすく注意が必要です。ノロウイルスの感染を防ぐためのポイントをここでチェックしましょう。 目次 冬に流行する、ノロウイルスによる感染性胃腸炎 有効な抗ウイルス剤はなく、感染の予防が何よりも大切 予防のポイントは手洗いと消毒 ノロウイルスの感染を防ぐためのポイント 冬に流行する、ノロウイルスによる感染性胃腸炎 風邪やインフルエンザと同じく、主に冬に流行する病気で注意が必要なのが、ノロウイルスによる感染性胃腸炎です。症状は嘔吐や腹痛、下痢などで、特に子供や高齢者は重症化しやすく、最悪の場合は嘔吐物がのどに詰まって死に至ることもあります。 有効な抗ウイルス剤はなく、感染の予防が何よりも大切 ウイルス感染症の多くは、抗ウイルス剤による治療が行われますが、ノロウイルスに有効な抗ウイルス剤は存在しません。そのため発症した際の治療として、症状が治まる1~2日の間、水分や栄養の補給に気をつけながら安静を保つことになります。脱水症状がみられる場合は、軽度であれば経口補水液の利用が、重度であれば病院での輸液などが必要となります。発症を防ぐには、感染の予防に努めることが何よりも重要と言えます。 予防のポイントは手洗いと消毒 ノロウイルスは、感染した人の便や嘔吐物から、人どうしの直接的な接触や、くしゃみや咳などのしぶきを通じて口に入り、感染します。感染を防ぐためには、次のポイントに気をつけましょう。なお、消毒に用いられる「次亜塩素酸ナトリウム」は、塩素系の消毒剤や、家庭用の漂白剤などに含まれています。パッケージに記載されている成分表などで確認し、使用上の注意をよく読んだうえで使いましょう。 ノロウイルスの感染を防ぐためのポイント ●食事の前やトイレの後などには、必ず手を洗う 手を洗う際は、石けんやハンドソープをしっかりと泡立て、ブラシなどを使います。指輪をしている場合は外すのとともに、普段から爪を短く切っておくことも大切です。 温水による流水で十分にすすいだら、清潔なタオルやペーパータオルなどで拭きとりましょう。石けんやハンドソープにノロウイルスを失活化させる効果はありませんが、手や指の汚れを落とすことで、付着しているウイルスが落ちやすくなります。 ●調理器具や食器などは清潔に保ち、熱湯で消毒する 包丁やまな板などの調理器具や、食器、ふきんなどは、使った後にすぐ洗剤で洗いましょう。次亜塩素酸ナトリウム(塩素濃度約200ppm)に浸すように拭くと、ノロウイルスを失活化できます。85度以上の熱湯で1分以上加熱することでも、消毒できます。 ●便や嘔吐物は、感染が広がらないように気をつけて処理する 感染者の便や嘔吐物の中のノロウイルスは、時間が経って乾燥し、空中に舞ったものが口に入って感染することがあります。処理するときには、使い捨てのマスクや手袋、エプロンなどを身につけ、ウイルスが飛び散らないように、ペーパータオルなどで静かに拭き取ります。次に、次亜塩素酸ナトリウム(塩素濃度約200ppm)で浸すように床を拭き取り、水拭きをしましょう。 子供や高齢者のおむつや、拭き取りに使用したペーパータオルや手袋などは、ビニール袋に密閉して廃棄します。このとき可能であれば、ビニール袋に廃棄物が浸る量の次亜塩素酸ナトリウム(塩素濃度約1,000ppm)を入れて密閉しましょう。処理した後は、ウイルスが屋外に出て行くように、空気の流れに注意して換気することも重要となります。 公開日:2012/12/17

冬に流行する傾向のある「マイコプラズマ肺炎」は、周期的に大流行する感染症のひとつ。患者の多くは14歳以下の子供ですが、流行時には成人も注意が必要。その予防法とかかってしまったときの対策を紹介します。 目次 感染ルートは、咳やくしゃみなど 乾いた咳が3~4週間続いていたら、もしかして… 予防の基本!手洗い・うがいをしっかりと 感染ルートは、咳やくしゃみなど 肺炎は多くの場合、微生物の感染によって引き起こされます。原因となる微生物は肺炎球菌、クラミジア、インフルエンザウイルスなど多数あり、その中のひとつである「肺炎マイコプラズマ」という細菌によって引き起こされるものは、マイコプラズマ肺炎と呼ばれます。年間を通してみられる病気ではあるものの、冬に増加する傾向があります。患者の約8割は14歳以下の子供ですが、周期的に大流行することで知られ、成人も注意が必要となります。 肺炎マイコプラズマが広まる主な経路は、咳やくしゃみのしぶきを吸い込む飛沫感染や、感染した人と直接触れ合うことによる接触感染などです。感染すると、多くは気管支炎までにとどまりますが、そのうちの一部が感染から2~3週間ほどの潜伏期間を経て、肺炎の発症へと至ります。 乾いた咳が3~4週間続いていたら、もしかして… マイコプラズマ肺炎は、血液検査や胸部X線検査(レントゲン検査)などによって診断されます。 主な症状として、次のようなものが現れます。 マイコプラズマ肺炎の主な症状 ●発熱 ●全身のだるさ ●頭痛 ●のどの痛み ●声のかすれ ●耳の痛み ●胸の痛み ●3~4週間の長期にわたる、痰がからまない咳 …など 次のような合併症を併発することもあります。 ●胸膜炎 ●心筋炎 ●肝炎 ●中耳炎 …など 治療には、抗生物質が用いられます。本来は効果があるはずの抗生物質が効かない「耐性菌」も存在しますが、その場合は別の抗生物質による治療が行われるので、いずれにしても早めに医師に診てもらうことが望ましいです。一般的に、2週間ほどで症状が治まると言われていますが、重症の場合は入院が必要になることもあります。 予防の基本!手洗い・うがいをしっかりと インフルエンザをはじめとするほかの感染症と同じく、マイコプラズマ肺炎の予防にも有効なのが、おなじみの手洗いやうがいです。また、すでにマイコプラズマ肺炎にかかっている人との接触は、できるだけ避けるようにしましょう。感染を広げないために、自分に咳の症状がある場合は、マスクの着用をこころがけましょう。咳が長引くなど、通常の風邪などと異なる症状があれば、早めに受診することが勧められます。 公開日:2012/11/26

膣カンジダ症は、カビの一種であるカンジダが原因で膣に炎症が起きる病気で、カッテージチーズのようなおりものが増え強いかゆみを発生させます。完治までのポイントや予防のための注意点を詳しく紹介します。 目次 主な症状は、白いおりものと強いかゆみ 治療は完治するまで根気よく まずは婦人科でおりもの検査を 主な症状は、白いおりものと強いかゆみ 膣カンジダ症はカンジダ膣炎とも呼ばれ、カンジダというカビの一種により、膣に炎症が起きた状態をいいます。症状としては、白色に近いカッテージチーズのようなおりものが増え、家事や仕事が手につかなくなるほどの強いかゆみを生じます。 カンジダ自体はヒトにとって常在菌であり、性別を問わず体のどこか、特に皮膚や膣、口腔内に存在することが多いようですが、通常は炎症を起こすことはありません。ところが、免疫力が落ちたときなどにカンジダが異常に増殖すると、体のどこかで炎症が引き起こされます。女性の場合、これが膣で起こると膣カンジダ症となります。また、性交、ほかの常在菌の減少、下着による強い締めつけ、膣周辺の不衛生、膣の頻繁な洗浄なども原因となります。 治療は完治するまで根気よく 膣カンジダ症の治療は主に、抗生物質による薬物治療が行われます。抗生物質には、膣内に直接挿入する膣錠や内服薬などがあり、投与期間はおよそ1~2週間。性交のパートナーが一緒に治療する場合もあります。薬物の投与により、おりものやかゆみが改善しても、しっかりと治療しておかないとすぐに再発する可能性があるため、途中でやめないようにしましょう。 まずは婦人科でおりもの検査を 思い当たる症状があれば、まずは婦人科で膣からおりものを採取し、カンジダによるものかを調べるおりもの検査を受けましょう。男性の医師の診察に抵抗を感じる場合は、医師もスタッフも全員が女性の婦人科クリニックもあります。治療中、あるいは予防として、日常生活では次のことに気を付けましょう。 日常生活で気をつけること ●陰部の乾燥を心がける ゆったりとした服や、通気性の良い綿の下着などを着用し、蒸れないように注意します。シャワーや入浴後はよく乾かし、濡れた水着や下着はまめに着替えるようにします。 ●膣のまわりを清潔に保つ 生理中は、ナプキンやタンポンの交換はまめにすること。また、排便・排尿時は前から後ろへふき取る、性交後は洗い流すといったことを心がけます。 ●ビデの使用はほどほどに 頻繁に使いすぎると、膣内に傷がついたり、刺激になることがあります。特に膣剤の使用中は薬剤が流れてしまい、治療効果が得られなくなるので注意が必要です。 ●入浴時に強く洗わない かゆみがあると石鹸などで強く洗いたくなりますが、それが刺激となり、炎症が悪化することがあるので要注意です。特に薬物治療中に入浴する際は、軽く洗い流す程度にします。 ●治療中の性交は控える パートナーに感染することのほか、性交自体が刺激となって症状が悪化することもあります。パートナーにも症状がある場合は、医師の診察を受けましょう。 ■関連記事 女性を悩ます排尿障害やデリケートゾーンの疾患「GSM」とは 日本抗加齢医学会セミナー 公開日:2012/09/10

数年ごとに流行する傾向にある風疹。女性が妊娠初期に風疹を発症すると胎児に悪影響を及ぼすこともあります。少女期に予防接種を受けていない女性は特に注意が必要です。 目次 主な症状は、リンパ節の腫れと発熱 法律の変わり目に生まれた人は、予防接種を受けていない!? 重症化することは少ないが、油断は禁物 主な症状は、リンパ節の腫れと発熱 春から夏にかけてかかる人が多い感染症のひとつに、風疹があります。俗に「三日はしか」とも呼ばれ、数年ごとに流行する傾向にあります。特に2012年の夏は、年半ばにして過去の年間報告数を大きく上回る、大流行の年となりました。 典型的な症状は、首や耳の後ろにあるリンパ節の腫れや、その数日後に起こる、微熱から38度前後の発熱などです。さらに、色が薄く小さな発疹が、多くの場合は顔から出はじめ、全身にまんべんなく広がります。発熱や発疹は3日から数日程度で治まりますが、リンパ節の腫れは1ヵ月程度続く場合もあります。大人が感染した場合は強い関節痛もみられ、1週間ほど仕事を休むことも珍しくありません。 風疹の累積報告数の推移(2008年~2012年)※2012年のみ第29週まで 出典:国立感染症研究所 感染症発生動向調査(IDWR)2012年29週(2012年7月25日現在) 法律の変わり目に生まれた人は、予防接種を受けていない!? 風疹を引き起こす風疹ウイルスは、主にくしゃみなどで飛沫感染する。幼児や学童が感染すると集団感染となる可能性もあり、「発疹が消失するまで登校(登園)することはできない」と法律(学校保健安全法施行規則)でも定められています。 かつては中学2年生の女子を対象に予防接種が行われていましたが、法律の変わり目に中学時代を過ごした1979年4月2日から1987年10月1日に生まれた人は、予防接種を受けていないことが多いようです。予防接種を受けていない女性が、妊娠初期に風疹に感染すると、胎児に先天性の白内障や心奇形になるなどの影響を及ぼすこともあります。そのため、妊娠可能な年齢の女性やそのパートナーは、抗体検査や予防接種を受けておくことが望ましいといえます。なお、現在は乳児期から定期予防接種が行われています。 重症化することは少ないが、油断は禁物 風疹自体は、いわゆる「はしか」よりも感染力が弱く、重症化することはあまりないため、治療が必要となることは少ないようです。しかし、ツラいと感じる症状が続く場合は、解熱鎮痛薬などが処方されることもあります。また、ごく稀に合併症を起こす場合もあります。風疹と診断された後、強い疲労感や頭痛、けいれん、意識障害などの症状がみられたら、すぐに医療機関を受診し、適切な治療を受けましょう。 公開日:2012/08/13

結核患者は2007年時点で国内に2万5千人以上にのぼり、現在も油断できない感染症です。全結核の約9割といわれる「肺結核」の予防と対策について説明します。 目次 結核は過去の病気ではない! 肺結核の症状と予防方法 しっかり治療して肺結核の再発を防ぐ 結核は過去の病気ではない! 人気若手女性お笑いタレントの発病で話題になった「肺結核」。「結核なんて、昔の病気ではないの?」と驚かれた方も多いのではないでしょうか。確かに、結核は、産業革命当時のヨーロッパで死因の3割以上を占めるほど大流行し、日本でも戦前には「不治の病」として恐れられ、正岡子規、石川啄木、樋口一葉などの多くの著名人も、結核を原因として亡くなっています。 ですが、1940年代以降に抗結核薬の開発が次々に行われ、結核医療が飛躍的に向上したため、結核の流行は徐々に衰退しました。ところが、80年代に入って、HIV感染者など免疫の落ちている人の間での結核発病、薬剤耐性を持つ結核菌の発生などが起こり、再び結核患者の増加が問題になってきたのです。 こうした状況の中、WHOでは1993年に「結核非常事態宣言」を発表。結核が過去の病気ではないことを各国に知らしめました。日本でも1999年に厚生省が「結核緊急事態宣言」を発表し、予防と感染拡大防止の対策を推進してきました。厚生労働省「結核登録者情報調査年報集計結果」(概況)によると、日本には2007年時点で2万5千人以上の結核患者が存在しており、現在も油断できない感染症であることを物語っています。 肺結核の症状と予防方法 結核は、通常は肺から始まり「肺結核」として発病します。リンパや血液を通してほかの臓器にも広がる「肺外結核」を発病することもありますが、全結核の約9割が「肺結核」です。症状には、次のようなものがあるので注意しましょう。 風邪と似ているからといって見過ごさないで!肺結核の症状 咳が2週間以上続く 黄色、緑色の痰が出る 37度台の微熱が2週間以上続き、寝汗が出る 疲れやすく、食欲が低下する 息切れや胸の痛みがある 血の混じった痰が出る 多くの場合、結核菌に感染してもすぐには発病しないため、感染に気付かずに数十年も過ごしてしまう人も多いようです。しかし、菌は体内で生き続け、疲労や病気、加齢などで体の抵抗力が低下したときに増殖して、発病してしまいます。 結核菌は、「空気感染」によって広がります。つまり、空気中に浮遊した結核菌を吸いこむだけで感染してしまいます。したがって、周りに発病者が出た場合には、ツベルクリン反応検査、胸部レントゲン検査、細菌検査によって、感染の有無を確かめることが大事です。ツベルクリン反応検査は通常直径10mm以上の反応で陽性とされますが、検査を行った場所に直径60mm以上の大きな反応が出たり、反応部位に水疱ができたりした場合には後ほど発病する可能性が高いようです。その場合、抗結核薬の投薬を行うことによって、発病を予防することができます。また、現在は乳児期にBCG予防接種を受けて、結核の免疫をつけることができます。しかし、一生涯免疫が続くわけではないため、効果の過信は禁物です。 肺結核の症状が疑われたら、マスクをして早めに結核科、呼吸器内科、内科を受診しましょう。地域の保健センターに問い合わせると、結核診療が可能な施設を紹介してもらえます。また、病院内では集団感染する疑いもあるため、放置していてはいけません。病院に着いたらまず、受付で自分が肺結核かもしれないということを申し出ましょう。 しっかり治療して再発を防ぐ もし、肺結核の感染が疑われる場合には、まず胸部レントゲン検査を行い、さらに、痰を採取して結核菌の有無を調べます。肺結核と診断された場合には、抗結核薬を服用して治療を行います。特に最初の2ヵ月間は、数種類の強力な薬をしっかり服用して殺菌する必要があります。医師の指示通りに治療を行えば、通常は、6~12ヵ月間で完了します。感染症法により、治療費の公費助成が受けられるため、地域の保健センターに問い合わせましょう。 症状が軽い場合には医師の判断のもと、通院治療が可能です。しかし、痰に多量の結核菌が発見され、症状が重い場合には、他人への感染を広げないためにも入院し、伝染の危険性が低くなるまで隔離して投薬治療と検査を行います。 肺結核は、きちんと治療を行えば短期間で退院でき、通院で服薬治療を続けながら通常の日常生活を送ることができる疾患です。しかし、自己判断で治療を中断すると再発する可能性もあります。医師の指示に従い、じっくり確実に治療を続けていくことが肝心です。 公開日:2009/05/18

食中毒は一年中みられますが、梅雨の時期には、O157をはじめとした大腸菌やサルモネラ菌などによる食中毒が問題になります。予防するには食品の管理はもちろん、しっかり手洗いをすることも重要です。今回は流水で手を洗う方法「スクラブ法」についてご紹介します。 目次 開幕しています!夏の食中毒シーズン戦 食品管理だけで食中毒は防げるか?? スクラブ法をマスターしよう 開幕しています!夏の食中毒シーズン戦 食中毒は一年中みられますが、梅雨明けが待ち遠しいこの時期には、O157をはじめとした大腸菌やサルモネラ菌などによる食中毒が問題となります。O157においては、学校や飲食店などで多くの人が感染し、話題となったことをご存知の人も多いでしょう。 食中毒を防ぐために、わたしたちはどのようなことに気をつければいいのでしょうか。 ■教えて!O157による食中毒ってどんな病気? 感染しても症状の出ない人もいますが、多くの場合は発熱、吐き気、吐く、胃やお腹が痛い、下痢といった胃腸症状がみられます。さらに抵抗力の弱い人では、溶血性尿毒症症候群や脳症などの病気を引き起こし、死亡することもあります。 食品管理だけで食中毒は防げるか?? 食中毒というだけに、食品の管理や調理に気をつかっている人は多いはずです。しかし、人から人への感染を防ぐには「手洗い」が重要だといわれています。もちろん食品管理も大切ですが、いくら新鮮な食材を使っていても細菌がついている手で調理をすれば感染してしまうからです。 では普段、あなたは何秒ほど手を洗っているでしょうか?手を水でぬらしただけで、手洗いをしているつもりにはなっていませんか? 医療施設では抵抗力の弱い患者さんが多いため、感染対策に力を入れています。その現場で手に付いた汚れを十分に落とすためには、流水のもと液体石けんをつかって15秒以上の手洗いをする必要があるといわれています。さらに推奨されている手洗い方法もあることをご存知でしょうか? ■教えて!固形石けんより液体石けんのほうがいいの? 乾燥していない固形石けんは、細菌が増殖しやすい場所のひとつになるため、液体石けんのほうが推奨されています。 スクラブ法をマスターしよう 流水で手を洗う方法をスクラブ法といいます。この方法をマスターし、トイレへ入った後、調理や食事をする前、下痢をしている乳幼児や高齢者の世話をしたときなど、石けんと流水でしっかりと手を洗って食中毒を予防しましょう。 スクラブ法をご紹介 (1)手を流水でよくぬらす (2)液体石けんを手のひらにとる (3)手のひらを洗う (4)手の甲を洗う(反対も同様) (5)指をからませて指の間を洗う (6)片方をじゃんけんのグーの形にし、その手の指の背や爪の部分を洗う(反対も同様) (7)親指をもう片方の手のひらで包み、親指をくるくると回すように洗う(反対も同様) (8)指先、爪の部分 をよく洗う (反対も同様) (9)手首をもう片方の手のひらで包み、手首をくるくると回すように洗う(反対も同様) (10)流水でよく洗い流し、ペーパータオルや乾燥し清潔なタオルで拭く(反対も同様) ■教えて!お湯で手を洗ってもいいの? お湯のほうが水より汚れが落ちやすいため、洗ってかまいません。しかし、皮脂をうばって手あれを起こすことがあります。手あれ部分には細菌が付着しやすいので、手洗いのあとにはハンドクリームなどを使い、手のケアをしましょう。 公開日:2008/06/30

夏になると活動的になるのは人間だけではない!害虫もさかんに動き回るのがこの季節。もしもアウトドアで、自宅で、害虫に遭遇してしまったら!?警戒すべき蚊やダニ、毛虫、ムカデの生態や、刺されたときの対処法を知っておこう。 目次 蚊 ~感染症に注意! ダニ ~アレルギーの仕掛け人 毛虫 ~近づいただけで炎症を起こすことも ムカデ ~物陰に潜むヒットマン ●最近は街中にも進出!ヒトスジシマカ(ヤブカ) 活動はおもに昼。逆に夜になると見られなくなる。生息しているのは、おもに雑木林や竹ヤブなどだが、最近は公園や人家など街中にも少なくない。 ●夜のハンター アカイエカ 夜間に吸血し、屋内にも侵入。しつこい羽音で安眠を妨げる。近くに獲物がいなければ、半径1キロ近くも飛び回り、ターゲットを探す。 ●都会でも増加中! チカイエカ 低温に強く、なんと冬も活動する。よく見られるのは、水洗トイレの浄化槽や、ビルの地下、地下鉄の線路際の溝などの水溜り。最近は都心でも増加中だ。 子どもは要注意!?どんな人のところに集まりやすい? 蚊をおびき寄せているのは、人間が発する二酸化炭素やにおい、熱、汗とともに分泌される物質など。したがって、体温が高めで、新陳代謝により汗や二酸化炭素をたくさん排出する子どもは刺されやすい。また、血液型がO型の人が最も蚊に好まれるという調査結果もある。これはO型の血液中に含まれる赤血球表面に花の蜜に近い物質がついているせいだとか。 感染症に注意! 蚊に刺されるということは、腫れ、かゆみだけの問題ではない。実は、蚊はさまざまな感染症の病原体を運ぶ怖い虫。思わぬ病気にかかることもある。次に挙げる感染症は、 日本国内でほとんど見られないが、海外旅行先などでは感染する可能性もある。 日本脳炎 流行地域はアジアなど。媒介するのはコガタアカイエカ。 デング熱南米、アフリカ、アジアなどで多い。ヒトスジシマカなどにより感染。 マラリアアジアやオセアニアなどで多い。ハマダラカ属の蚊が媒介。 ウエストナイルウィルス熱症アメリカで多い。イエカ属の蚊により感染。 黄熱病アフリカで見られる病気。ネッタイシマカが媒介。 ●新しい畳にうじゃうじゃ ツメダニ 新築だからと安心してはいられない。ツメダニは、比較的新しい家屋や、代えたばかりの畳で大発生することがある虫。刺されると8~48時間後に赤く腫れ、かゆみが起こる。 ●アレルギーの仕掛け人 ヒョウダニ 気管支喘息やアレルギー性鼻炎を引き起こすのが、ヒョウダニだ。寝具やカーペットなどほこりがたまる場所に繁殖する。糞や死骸がアレルゲン(アレルギーのもと)となるケースも。 ●刺されていることに気づかない!?マダニ ペストに似た野兎病、慢性関節炎を引き起こすライム病などを引き起こす、恐ろしいダニ。だが、刺されてもかゆみが起こらず、まったく気づかないことがある。 刺された場合は、あわてて引き抜いたりせず、周辺部の消毒を。すぐに皮膚科を訪ね、取り除いてもらおう。夏から秋にかけて、山林や藪などで刺されやすい。 ●疥癬を起こす ヒゼンダニ かゆい疥癬の犯人がこれ。患者との接触や、ネコなどのペット、衣類や寝具を介して伝染する。刺されやすいのは、手指の股、肘の内側、わきの下、乳房の下、陰部など。1ヵ月くらいで激しいかゆみが起こる。 かきむしると、細菌感染や炎症を起こし悪化しやすい。すぐに皮膚科を受診しよう。できれば、伝染しやすい家族も早めに診察を受けたほうがよい。 ●ご注意!大発生中のチャドクガ 異常気象のせいか、最近おおいに増えているチャドクガ。刺されると次第に炎症が広がり、猛烈なかゆみに襲われる。 発生のピークは毎年6月と9月。山茶花、椿、茶などのツバキ科の植物に生息することが多い。触れた場合はもちろん、近づいただけで毛が皮膚に付着し、炎症を起こすことも。 「洗濯物を取り入れるときは必ずよくはたく」「外で見かけたら、帰宅後すぐにシャワーを浴びる」など、予防策を。刺されたら、早めに皮膚科を受診しよう。 ●物陰に潜むヒットマン ムカデ ベランダや庭のプランター下などに潜んでいることが多い。刺されると激痛が走り、患部が大きく腫れあがる。 刺された場合は、危険なのですぐに引き離し、頭部を叩きつぶすこと。その後、患部の毒を流水に浸しながら徹底的に絞り出そう。こうした応急処置の後、なるべくすぐ専門医を訪ねるとよい。 ハイキングなどで野山や河原に遊びにいく場合は、できるだけ肌を露出しないことが大切。 長袖の上着、長ズボン、帽子の着用は必須だ!また、虫よけスプレ-や殺虫剤を使うとさらに効果的。たかが虫と侮らず、しっかりと対策を心がけよう。 公開日:2005年8月15日

私たち人間に癒しを与えてくれるペットは、もはや欠かせない存在です。ペットのための服、同伴で食事ができるレストランなども増えています。その一方でひそかに広がっているのが、ペットからうつる感染症です。 目次 ペットからの感染症 広がっているのはなぜ? イヌからの感染症 ネコからの感染症 プレーリードッグ・ハムスターからの感染症 小鳥からの感染症 カメ・ヘビ・ワニからの感染症 ペットからの感染症 広がっているのはなぜ? いったいなぜ、ペットからの感染症は広がりつつあるのでしょうか?第一の理由は、人間とペットの距離が急激に縮まっていることです。第二の理由は、海外からの輸入動物が多くなっていることが挙げられます。ヘビやカメ、サルなどが続々と国内に持ち込まれるようになりました。ですが、海外の動物たちは、私たちにとって未知の菌を保有している可能性も高いといえます。ペットはあくまで動物。したがって、伝染性の菌を保有している可能性はゼロではありません。 イヌ 狂犬病 発症すると、ほぼ100%死亡する恐ろしい病気です。日本では、昭和32年まで流行していました。感染したイヌに咬まれると、唾液中のウイルスが傷口から侵入します。その後、神経を冒し、脳へと移動します。うつ症状や興奮、麻痺などがあらわれ、最後は死に至ります。日本では撲滅されたからといって、安心はできません。輸入動物が感染している可能性もあるからです。万が一咬まれた場合は消毒薬や石鹸で洗浄すると、ウィルスが死滅しやすいようです。 ■予防法:ペットのワクチン接種は必ず行いましょう。特に輸入された動物の場合は不可欠です。 エキノコックス症 千島列島から流氷に乗って移動してきたキタキツネが感染源の病気です。北海道の地方病として扱われていましたが、転勤や引越しで、全国的な広がりが懸念されるようになりました。エキノコックスは寄生虫の仲間で、イヌはエキノコックスが感染しているネズミを食べたときに感染します。エキノコックスに感染したキツネやイヌの糞便から排出された虫の卵が、人間の口にはいると感染してしまいます。感染すれば、幼虫が肝臓に入り込み肝臓を侵食して増殖します。腹痛や黄疸症状があらわれ、肝不全を起こします。キタキツネからイヌ(特に野犬)への感染、そしてイヌからヒトへの感染もおそれられています。 ■予防法:イヌがネズミを食べたりしないように注意します。北海道でキタキツネや野犬と接触しないようにすること。沢の生水なども飲まないようにします。 パスツレラ症 ネコ以外にも、イヌやウサギから伝染する病気です。ネコではなんとほぼ100%、イヌは約70%がこの菌を保有しています。 感染経路はふたつ。咬まれたり、ひっかかれたりする場合と、空気中の菌を吸って伝染する場合とがあります。傷ができた場合は、傷口がひどく痛み、赤く腫れたりします。気管支炎などの持病がある人は、菌を吸い込むことで、慢性の呼吸器感染症となることもあるようです。特にお年寄りや、糖尿病患者など抵抗力の弱い人は、感染しやすいので注意が必要です。 ■予防法:病気療養中の人は、ペットと過度なスキンシップを避け、咬んだりひっかいたりしないようにしつけます。また、部屋の空気を清潔に保つようにしましょう。 ネコ Q熱 「体がだるい」「ヤル気が起きない」――まるでうつ病のような症状ですが、これがこの病気の特徴です。長期にわたる疲労感、不定愁訴、発熱などが見られます。近年では、「慢性疲労症候群」との関わりも指摘されるようになりましたが、原因は、ネコとの過剰な接触です。口移しで食べ物を与えたり、キスしたりすると感染する可能性があります。 ■予防法:口移しをするなど過剰な接触をせず、触れたら必ず手を洗いましょう。 ネコひっかき病 ネコにひっかかれたり、咬まれたりすると感染します。また、ノミからうつされることもあります。症状はリンパ節のはれ、発熱、ズキズキとした痛みです。保菌しているネコにはほとんど症状がないので、注意が必要です。感染しやすいのは子供で、発症者の半数が15歳以下となっています。また、発生しやすいのは7~12月頃といわれています。 ■予防法:ネコに触れたら必ず手洗い、消毒をおこないます。ノミの駆除もしておくとよいでしょう。 プレーリードッグ・ハムスター 野兎病(やとびょう) 本来は野ウサギや野ネズミなど野生のげっ歯類の病気です。生物テロに利用される可能性があるとして、世界中が警戒している菌です。感染した動物に触れたり、汚染した糞便が塵となったものを吸いこんだり、菌を持ったダニに触れたりするとうつります。症状は突然あらわれます。高熱、頭痛、全身の痛み、鼻水、咳、胸痛などです。放っておくと肺炎や敗血症、髄膜炎を起こすこともあります。戦後は毎年のように多数の発症者があらわれましたが、その後ほとんど感染する人はいなくなりました。ところが最近、米国のプレーリードッグの間で流行が起こりました。日本にも多く輸入されている動物だけに、油断できない病気です。 ■予防法:ペットのダニは素手で潰さないようにします。ペットが死んだら体に触れないようにします。 小鳥 オウム病 オウムやセキセイインコなどから感染します。菌は糞便に排泄され、それが乾燥して空中に舞うと、人間が吸いこんで感染してしまうことが多いようです。発症すると発熱、咳、肺炎、筋肉痛などインフルエンザに似た症状が起こります。もしも似たような兆候が見られ、なおかつ飼っている鳥が、羽毛を逆立てていたり、下痢していたら、オウム病の可能性は大です。インフルエンザ治療薬は効かないので、必ず医師にそのことを告げましょう。 ■予防法:口移しでエサをやらないようにします。また、トリに触ったら必ず手を洗います。鳥カゴはいつも清潔にするように心がけましょう。 カメ・ヘビ・ワニ サルモネラ症 病原性大腸菌症、腸炎ビブリオと並ぶ、3大食中毒です。ハ虫類のほか、ウシ、ブタ、ニワトリ、イヌ、ネコもサルモネラ菌を持っています。特に小さなミドリガメは保菌していても、外見上は何も変化が見られないので、要注意です。感染すると、8~48時間で発症します。腹痛、下痢、発熱、血便が起こります。免疫力のない病人やお年寄り、子どもの場合は死亡することもあります。 ■予防法:ペットを触ったあとは、よく手を洗います。また、家族に幼児がいる場合は、カメなどのハ虫類を飼わないほうがいいかもしれません。 公開日:2005年10月3日

夏のウイルス性感染症(夏風邪)の発症時期は5月から8月。今回は、手足口病やヘルパンギーナ、プール熱などウイルスが原因である感染症を中心に、夏の感染症の原因や症状をご紹介します。感染症は大人だけでなく子供にも注意しましょう! 目次 夏の感染症、どうして流行るの? 夏の感染症の原因と症状 プールで感染しやすい病気 家庭でできる「感染症予防対策」 ほかにもある!こんな感染症に要注意 夏の感染症、どうして流行るの? 夏は、厳しい暑さから食欲不振になったり、生活習慣が乱れやすく夜更かしが続いたりして、なにかと体調を崩しがち。そんな私たちを狙っているのが感染症です。 感染症とは、ウイルスや細菌、真菌、微生物などが皮膚や粘膜などから体内に侵入して増殖し、さまざまな症状を起こす病気のこと。 夏場に流行る感染症のうち、今回は手足口病、プール熱、ヘルパンギーナなど、ウイルスが原因の感染症について考えてみましょう。 夏のウイルス性感染症の発症時期は5月から8月といわれ、主な症状は胃腸が不調になること。体全体の免疫力がダウンするため、長引くことも多いようです。 この季節、ウイルスは独特の方法で私たちの体に侵入してきます。 「咽頭結膜熱」は通称プール熱といい、特に児童が感染しやすいようです。病気の元である「アデノウイルス」は便や唾液を通じて感染しますが、特にプールの水から感染する確率が高いとされています。 このように、プールの後よく目や体を洗わないことや、タオルの貸し借りなどの機会を通じて、人から人へと感染者を増やすのが夏場のウイルスの特徴です。 夏の感染症の原因と症状 手足口病 ●主な原因ウイルス:コクサッキーA16、コクサッキーA10、エンテロウイルス71…原因であるウイルスは10種類以上あります。 ●症状など:手足の水疱と口内炎ができる夏風邪の一種。胃腸風邪ウイルスからくる少々の下痢の症状を伴います。初日から2日目に熱が出ますが、それ以後熱は出ず、5日ほどで症状は回復します。髄膜炎になることもあり注意が必要です。 リンゴ病 ●主な原因ウイルス:パルボウイルスB19 ●症状など:咳、鼻汁、微熱など軽い風邪の症状が出ます。その後、赤い発疹がほおの辺りに出て、その後手足にまで広がります。接種で予防ができず、不明な部分が多い病気です。 ヘルパンギーナ ●主な原因ウイルス:原因ウイルスは多数あるといわれていますが、主にコクサッキーA群だと考えられています。 ●症状など:高熱が長く続き、のどの奥に口内炎ができる特徴があります。予防接種がないので、毎年発症する子どももいます。 子供によくみられる夏風邪「ヘルパンギーナ」 風疹 ●主な原因ウイルス:風疹ウイルス ●症状など:初春から夏の終わりにかけて多発。発疹が胸と顔から広がり、リンパ腺が腫れるのが特徴です。多少の熱が伴いますが、4~5日で症状はひいていき2週間ほどで感染期間が終わります。症状がひくまでは幼稚園・学校を休ませます。また妊娠中に風疹にかかると障害をもった子どもが生まれる確率が高いとされているので十分な注意が必要です。 数年ごとに流行を繰り返す「風疹」にご用心! プールで感染しやすい病気 プール熱 ●主な原因ウイルス:アデノウイルス ●症状など:正式には「咽頭結膜熱」といい、7月から9月のプールに入る時期に流行ることから通称プール熱と呼ばれています。高熱を伴い、のどと目の両方に炎症を起こします。死亡例も報告されており、重症化する可能性が大きい病気です。治った後もウイルスが咽頭や便からうつるケースが多いようです。 流行性結膜炎 ●主な原因ウイルス:アデノウイルス ●症状など:目やにが出て、結膜が充血します。感染力が強く、乳児がかかると風邪の症状を伴うことが多く見受けられます。その症状は発熱やリンパ節の腫れなど。年中気をつけなければいけない病気ではありますが、特に夏はプールなどで人と接触しやすい季節なので気をつけることが大切です。 水イボ ●主な原因ウイルス:ウイルスによる良性イボ ●症状など:「伝染性軟属腫」といい、そのほとんどは自然に治ります。一度かかると免疫ができるので次に発症することはありません。ピンセットでつまんで取り去る方法など治療方法はいろいろあります。また、伝染性と呼ばれていますが、肌を露出した人と接触さえしなければ、うつることはありません。 家庭でできる「感染症予防対策」 感染症を予防するには、毎日の心がけが肝心です。外出先から帰ったときや食事前の手洗いを習慣づけるだけでも、ずいぶんと予防につながります。「自分だけはキレイ」と思っている人も多いかもしれませんが、、大人の中にも手洗いの習慣がついていない人がたくさんいます。子どもの泥汚れとは違い、目に見えない汚れが多いので、爪の間などしっかりと丁寧に洗いましょう。濡れたままの手で、髪の毛を触らないことも大切です。 また、夏休みにはアウトドアなど楽しむ機会が多くなりますが、外での食事の支度時は、念入りに手や食材を洗う、食材に十分に火を通すなど衛生管理につとめるようにしましょう。 手洗いするときの注意点 ●食事の前、トイレに入った後、外出先から帰宅したら手を洗うように習慣づける ●洗うときは手首まで洗うことが大切 ●洗った後は清潔なタオルや布でふくようにこころがける 手洗いを見直そう! 夏のバーベキューもこれで安心!屋外での食中毒予防の心得 体全体の免疫力を高めておくことも予防のポイント。休養を十分にとり、栄養バランスがとれた食事を。特に粘膜の材料となるたんぱく質や、免疫細胞を強化するビタミンA・C・E、腸を元気にする乳酸菌や食物繊維などを意識して摂りたいものです。日焼けをして肌が乾燥すると免疫力の低下につながることも覚えておきましょう。 もし感染症を発症したら、ほかの人に感染しないように注意することも必要となります。下痢が続く、高熱が続くなどの症状が見られた場合は、直ちに医師の診断を受けるようにしましょう。 ほかにもある!こんな感染症に要注意 長期の休みに入ると家族で海外旅行に行く人も多いことでしょう。そんな時、海外でも感染に気をつけなくてはいけません。 海外旅行に出かける人は渡航先の感染情報を入手し、それぞれの国に対応した予防接種を受けること。渡航先では生ものや生水にも注意が必要です。日本とは違う環境であることを忘れずに。 またバカンスでつい気を緩めてしまいがちですが、STD(性感染症)のリスクがあることを常に心しておきましょう。 海外旅行・海外出張の前に予防接種を!インフルエンザ対策もお忘れなく 感染症にかからないように十分に気をつけて、楽しい夏をお過ごしください。 ■関連記事 子供によくみられる夏風邪「ヘルパンギーナ」 海外旅行の怖いお土産 感染症で下痢・嘔吐 公開日:2005年7月25日更新日:2018/05/28

天然痘、結核…。かつて人々を脅かした多くの伝染病が、ワクチンの開発により、あたかも地上から姿を消したかのように思われている。しかし近年になって、忘れ去られていた感染症がとつぜん、流行し始めてもいる。予防接種は大切な「転ばぬ先の杖」。感染を広げないためにも、なるべくなら受けておこう。 目次 予防接種にはどんな種類があるの? 予防接種はみんなが受けなくてはいけないの? 予防接種は大人も必要なの? こんなときは接種を避けよう 予防接種にはどんな種類があるの? ●生ワクチン 生きたままの病原菌を、毒性を弱めてつくったワクチン。接種することでその病気にかかったときと同じ状態にし、免疫を作り出す。ただし、きちんと免疫ができるまでは時間がかかるので注意が必要。また、接種後は発熱、発疹などが起きやすい。 …BCG、ポリオ、麻疹(はしか)、風疹(ふうしん)など ●不活化ワクチン・トキソイド ウィルスや細菌をいったん殺し、必要な成分だけを抽出してつくったワクチン。病原菌は体内で増殖しないので、何度か接種することで、細胞に抗原を記憶させ免疫をつくる。 …日本脳炎、DPT・DT(3種混合・2種混合)など 予防接種はみんなが受けなくてはいけないの? もちろん、予防接種を受けることは義務ではない。厚生労働省は、ぜひ受けるように努力してほしい予防接種「勧奨接種」として以下の7つを挙げている。ちなみに対象者なら無料だ。そのほか、できれば受けておきたい任意の予防接種もある。 接種回数 標準的な接種年齢 対象年齢 BCG 1回3~4ヵ月4歳未満のツベルクリン反応陰性者 ポリオ 2回3ヵ月~1歳6ヵ月3ヵ月~7歳6ヵ月 DPT 3種混合(DT 2種混合) 1期初回3回3ヵ月~7歳6ヵ月 1期追加 1回1期終了後1年~1年6ヵ月後3ヵ月~7歳6ヵ月 2期(DT)1回小学校6年11~12歳 麻疹(はしか) 1回1~2歳未満1~7歳6ヵ月 風疹(ふうしん) 1回1~3歳未満1~7歳6ヵ月 日本脳炎 1期初回 2回3歳6ヵ月~7歳6ヵ月 1期追加 1回4歳6ヵ月~7歳6ヵ月 2期 1回小学校4年9~13歳 3期 1回中学校2年14~15歳 インフルエンザ※ 1回毎年接種が必要65歳以上、60~65歳の一部 ※65歳以上、60~65歳未満の人の一部には、「2類勧奨接種」とされている 1年間に計6回!? 意外と多い0歳代の予防接種 できれば受けておこう(任意) 接種回数 対象年齢 おたふくかぜ 1回1歳~ 水痘 1回1歳~ インフルエンザ 13歳未満2回13歳以上1回毎年接種が必要指定なし(通常6ヵ月~) A型肝炎 3回16歳~ B型肝炎(母子感染予防) 3回0歳~ B型肝炎(一般) 3回 接種したほうがいい?!1歳以降の予防接種 予防接種は大人も必要なの? ●高齢者はインフルエンザワクチンを インフルエンザは重症化すると気管支炎、細菌性肺炎などを引き起こしかねない怖い病気。ワクチンは、その年の冬、流行する可能性のあるA型インフルエンザウイルス2種と、B型インフルエンザウイルス1種を混合したものが、毎年あらたに製造される。流行株とワクチン株が一致すれば、予防効果は期待できる。2001年の予防接種法改正以来、高齢者への接種が一部公費負担で実施されるようになった。 ●妊娠・出産を考える女性は風疹、麻疹ワクチンを これから妊娠・出産をひかえる女性におすすめなのが風疹(ふうしん)、麻疹(はしか)ワクチン接種。ことに大人の麻疹は最近、日本各地でみられるようになり、油断はできない。また、1979年4月2日~1987年10月1日生まれで、風疹にかかったことがない女性も、ぜひ予防接種を受けておこう。ただし、接種後3ヵ月間は避妊が必要。詳しくは専門医に。 数年ごとに流行を繰り返す「風疹」にご用心! ●海外旅行前に予防接種を このほか海外旅行に行くときにも、ぜひ予防接種を受けておこう。感染症が流行している地域を訪れる場合はなおさら。破傷風、A型肝炎、日本脳炎、ポリオ、ジフテリア、麻疹(はしか)、狂犬病の予防接種を受けたことのない人は、流行状況を調べたうえで、積極的に受けるとよいだろう(ただし、A型肝炎予防接種を受けられるのは16歳以上のみ)。 東南アジア、インド、南アフリカなど、入国に際し、黄熱ワクチンの接種済み証明書を求める国もある。 海外旅行・海外出張の前に予防接種を!インフルエンザ対策もお忘れなく 海外にはどんな薬を持っていけばいい?現地で買うときの注意点は? こんなときは接種を避けよう 不健康な状態では予防効果どころか、危険な状態に陥ることも。こんなときは予防接種を避けよう。 ●発熱している ●重い急性疾患にかかっている ●アレルギーを持っている ●妊娠している 予防接種の実施は、市町村によって方法や時期が異なる。集団接種をおこなう場合もあれば、個別接種をする所もある。詳しくは地域の保健センターなどに問い合わせよう。 参考サイト:国立感染症研究所 感染症情報センター 公開日:2004年3月15日

ずっと楽しみにしていた海外旅行なのに、ひどい下痢や嘔吐でホテルから一歩も出られなかった――こんな経験はないだろうか?海外旅行には感染症の危険がつきもの。基本的な知識をおさえたうえで、しっかり予防しよう。 目次 こんな感染症に注意!飲み物・食べ物で移る病気 どうやって予防する?旅行前・旅行中・旅行後 もしも感染症にかかってしまったら? こんな感染症に注意!飲み物・食べ物で移る病気 A型肝炎 主な症状…黄疸、発熱、悪心、嘔吐 原因 …水、氷、野菜や果物、魚介類など 感染地域…東南アジア、中東、アフリカ、南米など 説明 …潜伏期間は約30日。帰国してから発症することが多い。最初は眼の白目部分が黄色くなるなどの黄疸症状が。さらに発熱、悪心、嘔吐などが起こる。 コレラ 主な症状…下痢、嘔吐、脱水症状 原因 …水、氷、魚介類、野菜、果物など 感染地域…アジア、中南米、中近東など 説明 …死亡の危険は少ない「エストール小川型」と、致死率のやや高い「アジア型」がある。 アジア型では嘔吐に加え大量の下痢がある。便が米のとぎ汁状なら警戒を! 赤痢 主な症状…発熱、腹痛、下痢、血便、しぶり腹(排便後もスッキリしない症状) 原因 …水、氷、魚介類、野菜、果物、食器など 感染地域…アジア、アフリカ、中近東など 説明 …感染して2日ほど経った頃に発熱、腹や左下腹部に痛みが起こり、下痢が始まる。 重い場合は日に数十回もトイレに行くこととなる。便に粘液や血膿がまじるのも特徴だ。 サルモネラ食中毒 主な症状…下痢、腹痛、嘔吐、発熱 原因 …肉、卵、ヨ-グルトなど乳製品など 感染地域…アジア、中近東、アフリカ、ヨーロッパ、アメリカなど 説明 …水様便の下痢が続き、便には粘液、血膿が含まれる。まれに黄疸症状が起こることも。健康な大人であれば回復することが多いが、お年よりや子どもの場合は重症化する例も。 腸チフス・パラチフス 主な症状…下痢、発熱、便秘、バラ疹(腹部や内腿にあらわれる小指爪くらいの発疹) 原因 …水、氷、魚介類、野菜、果物、食器など 感染地域…アジア、中東、東欧、アフリカ、中南米など 説明 …腸チフスの潜伏期間は1~3週間。だんだん体温が上がり、下痢や便秘、バラ疹などの症状が。重症化すると高熱から意識障害も。パラチフスも経過はよく似ているが、症状はやや軽い。 どうやって予防する?旅行前・旅行中・旅行後 旅行前 健康状態をチェック ただでさえ、疲労やストレス、時差などで抵抗力が低下しがちな海外旅行。出発時の体調は万全を期しておきたい。ちょっとした風邪や胃腸の不調なども治しておこう。 予防接種について A型肝炎はワクチンで予防することができる。流行地域に旅行するときは、事前に2回、接種を受けよう。この際、2週間~1ヵ月、間をおかなければならないので、時間がないときは免疫グロブリンという薬品の接種を受ける。効果が持続する期間は約2週間と限られているので、注意が必要だ。 このほか国内で受けられる予防接種にコレラワクチンがあるが、予防効果はあまり期待できない。健康に問題のある人やお年寄りなどは、念のために接種するとよいだろう。 旅行中 こんな食べ物は注文しない。出てきた場合は思いきって残そう 生もの…生野菜・カットフルーツ・半生や生の肉や魚など 生水…水道水・氷入りのジュース・ウイスキーやブランデーの水割り 卵・乳製品…生卵・自家製アイスクリームやマヨネーズ ・調理後、時間がたった卵料理など このほか、汚れた食器での食事などは避けたいもの。また、衛生面で問題のないような国でも、卵や生カキ、刺身による感染症は多発している。油断は禁物だ! スケジュールは余裕を持って 寝不足や疲労は、免疫力を低下させる。無理をせず、ゆとりを持って行動するようにしよう。 手は清潔に トイレのドアノブなどから感染することもある。食事の前などは必ず手を洗うよう心がけたい。 旅行後 潜伏期が長く、感染してもすぐには発病しない病気もある。海外旅行から帰って来たら体調には十分、注意を。2次感染を防ぐためにも、少しでも異変があれば早めに病院を訪ねよう。 もしも感染症にかかってしまったら? 下痢症状があらわれたら、まずは十分に水分補給を。ペットボトルのミネラルウォーターやスポーツドリンクを飲むとよいだろう。しばらく様子をみて、血便などの症状があらわれたら、すぐ専門医に受診を。 海外での治療費は割高なので、長旅の場合は事前に海外旅行障害保険に加入しておくことをオススメする。手遅れにならないうちに、早めの対応を心がけよう。 参考文献・サイト: 海外のあぶない病気(コスモの本・刊) 厚生労働省検疫所 FORTH 海外渡航者のための感染症情報 公開日:2003年12月1日

アニマルセラピーは科学的な立証が難しいものの、血圧の安定などいくつかの効果がデータとして紹介されている。またペットと暮らす上での注意点としてペットロス、感染症についてもまとめた。 目次 アニマルセラピーがもたらす利点と注意点 あなたとペットが健康に暮らすために アニマルセラピーがもたらす利点と注意点 動物の存在が人間の心身の健康によい影響を与えるらしいということは、多くの人が経験を通してなんとなく知っていることではないだろうか。だが、精神状態の尺度を設けることが難しいなど、アニマルセラピーについて医学的・科学的に実証していくのは困難だ。それでもいくつかデータとして発表された報告もある。 アニマルセラピーの効果 生理的な効果 病気の回復、血液やコレステロール値の低下 神経筋肉組織のリハビリ(乗馬療法) 心理的な効果 リラックス、くつろぎ感を増し、不安を減らす 責任感、心理的自立を促す 達成感(乗馬療法) 社会的な効果 人間関係を結ぶきっかけとなる 集団のまとまり、協力関係の推進 身体的、経済的な自立を促す(盲導犬、聴導犬) アニマルセラピーは、人と動物がただ触れ合えばいいというものではない。当然ながらアニマルセラピーが適応しないケースもある。 アニマルセラピーが適応しないケース 動物の存在が人間にとってマイナスになる場合 動物による感染症が心配されるとき 各種アレルギーが心配されるとき 動物が嫌いな人に対して 人間の存在が動物にとってマイナスになる場合 動物虐待や世話の放棄などが心配されるとき あなたとペットが健康に暮らすために 毎日の生活に活気を与えてくれたり、安らぎを与えてくれるペット。家族の一員としても大切な存在だ。人間と動物が共に健康的に暮らすために、いくつか気をつけておきたいことがある。 ペットロス ペットが死んだ後の飼い主の悲しみを「ペットロス」と呼ぶ。食欲がなくなったり、意欲がわかなくなって仕事などにも支障をきたすようになり、ひどくなると抑うつ的になってしまうケースもある。 ペットの死の悲しみについて、なかなか人に話しにくい、理解されにくいということから重いペットロスに陥ってしまうこともあるようだ。 では、どうしたらペットの死ときちんと向き合えるのだろうか。 例えば犬の寿命は15~20年と言われている。ほとんどの場合は確実に犬の方が先に死んでしまい、自分がその最期を看取らなくてはいけない。当たり前のことだが、このことを飼い始める際によく理解しておくこと。また、ペットとの距離感も大切。例えば動物園の飼育係は愛情を抱きながらも一定の距離をおいて動物と付き合っているため、死別を経験してもペットロスにはならないという。くれぐれも過剰にペットにのめり込むことのないよう注意したい。 感染症 ヒトから他の動物に、あるいはヒト以外の動物からヒトに感染しうる疾患のことを「人畜共通感染症」と言い、日本の場合ペットに関する人畜共通感染症はおよそ30種類もあると言われている。なかには重い症状につながりかねないものもあるので、あなたとペットの健康を守るために以下のことに気をつけて欲しい。 ●咬んだり引っかいたりしないようにしつける ●家の中や敷地内ではトイレを決め、その場所で必ず行うようにしつける ●感染の可能性のある場所にペットを近づけない ●ペットと遊んだ後はきちんと手を洗う、口移しやキスをしない、同じ食器を使わない ●珍しいもの、希少価値のあるもの、野生動物をペットとして飼うのは危険 ●定期的に獣医の健康診断を受けさせ、感染症のニュースにも注意しておく 主な人畜共通感染症 犬 犬回虫症、犬糸状虫症、皮膚糸状虫症、白癬菌感染症、サルモネラ腸炎、狂犬病、パスツレラ症など 猫 猫ノミ刺症、ダニ皮膚炎、猫回虫症、トキソプラズマ症、Q熱、皮膚糸状虫症、白癬菌感染症、サルモネラ腸炎、狂犬病、パスツレラ症など げっ歯類※ 白癬菌感染症、リンパ球性脈絡髄膜炎、ダニ皮膚炎、サルモネラ腸炎など ※ウサギ、モルモット、ハムスター、マウスなど 小鳥 トリサシダニ刺症、鞭虫症、サルモネラ腸炎、オウム病、クリプトコッカス症、結核など 公開日:2003年3月17日

夏にピークを迎える食中毒。「ただの腹痛だろう」なんて甘く見ていると取り返しのつかないことに…。食中毒を未然に防ぐにはどうしたらいいのでしょうか。 目次 全国各地で発生!夏の食中毒 夏の食中毒の原因は、約8割が「細菌」 弁当で食中毒にならないために 全国各地で発生!夏の食中毒 「ただの腹痛だろう」と甘く見ていると、取り返しのつかないことになりかねないのが、夏の食中毒です。梅雨の時期を迎えると、下痢や腹痛、嘔吐などの症状が全国各地で出たというニュースを耳にすることも多くなるでしょう。届け出のない場合もあるので、実際の食中毒の被害者は、報道されている人数より多い可能性もあります。 夏の食中毒の原因は、約8割が「細菌」 何が原因で食中毒になることが多いかは、時期によって異なります。冬であれば、ノロウイルスをはじめとしたウイルスによる食中毒が多いのですが、夏は細菌が食中毒の原因の多くを占めます。食中毒を引き起こす細菌には、次のようなものがあります。原因食品に挙げられているものを口にする際は、特に注意が必要と言えます。 ●腸管出血性大腸菌[O157、O111] 牛肉・牛レバー刺し・貝割れ大根などが主な原因食品 ●サルモネラ属菌 牛レバー刺し・鶏肉・卵などが主な原因食品 ●腸炎ビブリオ 魚や貝などの海産物が主な原因食品 夏の食中毒の原因物質 (2013年6月~8月:患者数3,008人) 出典:厚生労働省 食中毒統計資料 弁当で食中毒にならないために 食中毒の基本的な対策として重要なのが、手洗い、調理器具の消毒、肉・魚の十分な加熱などです。これに加えて、食べ物が傷みやすい夏は、自宅から学校や職場に持っていく弁当に特に注意して、次のような対策をとることを心がけましょう。 ■水気を十分に切る 細菌は、水分が多い環境で増殖しやすいので、おかずの汁気をしっかりと切りましょう。ご飯やおかずの湯気は、冷えると水になってしまいます。弁当箱に詰める前に、冷蔵庫に入れるなどして冷ますようにしましょう。 ■作りおきしたおかずはなるべく使わない 前日の夕飯のおかずを弁当に詰めることはよくありますが、食中毒のリスクを考えると、夏はなるべく避けたいものです。使いたいときは、冷蔵庫で保管しておき、再び火を通してから冷まして弁当箱に詰めるようにしましょう。 ■冷凍食品もしっかり加熱する 毎日の弁当で重宝する、冷凍食品のハンバーグや唐揚げなどにも、食中毒のリスクはあります。冷凍する前に調理済みだからといって油断せず、しっかりと加熱しましょう。 ■弁当箱はきちんと洗う 弁当箱のふたには、パッキンと呼ばれるゴムが付いている部分があります。ここは汚れが残りやすいので、分解して洗うと良いでしょう。洗った後は、しっかりと乾かしましょう。 公開日:2014年6月30日

ペットは欠かせない大切な存在という方も多いでしょう。しかし、過度なスキンシップで、ペットから寄生虫がうつってしまうことも…。ペットとの付き合い方を知っておきましょう。 ペットとの同居で増えた人畜共通感染症 飼っている動物から人に感染する病気があることをご存じですか? 人畜共通感染症といって、人とせきつい動物の間を寄生体(病原微生物や寄生虫)が移動することによって起こる感染症です。 家屋内でさまざまな動物が人間と同居するようになり、ペットを介してうつるこの人畜共通感染症が増えています。 ペットを飼う際は正しい知識を 主な人畜共通感染症は以下のとおりです。 病名 感染経路 症状 注意点 犬回虫症 子犬のふんがに含まれている虫卵を、人間が飲みこんでしまうと感染 せき、発熱、白血球増加、肝臓が腫れるなど 幼犬は100%近く犬回虫に感染しているので、子犬を飼うときには必ず駆虫。 その後も定期的に検査を行うこと。子供が遊ぶ砂場も、犬のふんが混ざっている危険があるので注意を 犬糸状虫症 糸状虫を含む犬の血を吸った蚊が人を刺すことで感染 大部分は肺に寄生する 胸部X線撮影をすると、円形の影となって見えるため、肺がんと誤診されることも エキノコックス症(包虫症) オオカミ、キツネ、犬のふんに含まれる包虫卵を、草や水などと一緒に飲み込んでしまうことで感染 肝臓に定着することが多いが、肺、脳、骨などに病変が見られることも。寄生している臓器の圧迫、肝臓の腫れが見られる 北海道に広く分布しており、キツネや犬の感染が進んでいるので、これらの動物のふんで汚染された土地の水や草には注意。飼い犬には、定期的に検便を トキソプラズマ症 猫のふんから経口感染する。このほか、豚や羊の生肉から摂取して感染することもある ふつうは無症状。ただし、抵抗力が弱っていると、リンパ節炎、肺炎、肝障害などが起こることがある 抗体を持たない妊婦が感染した場合、胎児にも感染して水頭症※になる危険がある オウム病 クラミジア・プシッタシーとよばれる病原体が、オウム、ハトなどに寄生して分裂・増殖。 感染・発病した鳥の排泄物などから人が吸収することによって発症 風邪と同じ症状、激しいせき、重症の場合には呼吸困難も起きる 心筋炎、心内・外膜炎、髄膜炎を起こすことも オウム病は、通常鳥から人へ感染するが、最近、人から人へ感染する事例も見つかった。家族がオウム病と診断されたら、全員が検査を受けること ※水頭症 髄液が脳の中心部にたまり、生後1~2ヵ月から頭囲が大きくなってくる病気。 放置しておくと、脳の実質が圧迫され、発育・発達が妨げられます。 手足の麻痺やけいれん、知能障害もおこります。 感染予防のためにはペットの健康管理はもちろん、正しい知識と予防法を知ったうえでペットを飼うことが必要です。口移しにエサをやる、イヌやネコになめられるなどといった行為は、感染の危険を大きくします。
過去の話ではない寄生虫病 日本では寄生虫病はもう過去の話と思われがちですが、最近は少々違った様相を呈してきています。たしかに、回虫・こう虫・べん虫などの腸管寄生虫は、ほとんど見られなくなりました。 ところが、それに代わって獣肉、鳥肉、魚肉、そのほかは虫類、両生類などの生食いし好により、寄生虫に感染するケースが増加しています。特にゲテモノし好がグルメ呼ばわりされ、感染増加を助長していると考えられます。 少なくない輸入寄生虫病 マムシやヘビによる有線条虫症、ヘビ・カエル・鳥肉の生食によるマンソン裂頭条虫症、クマ肉のルイベによる旋毛虫症、ドジョウの踊り食いによるがく口虫症など、いろいろなケースが報告されています。予防のためには、少なくとも生食を避けることが必要です。 一方で、輸入感染症と呼ばれるものの中には、原因が寄生虫である輸入寄生虫病(持ち込み寄生虫病)も少なくありません。いずれにしても予防接種や感染した場合の適切な処置が求められます。

細菌や毒素を攻撃する免疫グロブリン 血しょうの約90%は水分で、残りの大部分がたんぱく質です。血しょうたんぱくの主な構成成分はアルブミン、α1-グロブリン、α2-グロブリン、β-グロブリン、γ-グロブリンです。 ところで、私たちの体には、体内に一度入ってきた細菌や毒素などの異物を確認して攻撃する免疫力が備わっています。この作用を担うのが抗体で、免疫グロブリンと呼ばれるたんぱく質でできています。この免疫グロブリンの主成分がγ-グロブリンなのです。 抵抗力が落ちるγ-グロブリン不足 つまり血しょう中のたんぱく質が不足するということは、γ-グロブリン不足を意味します。γ-グロブリンが不足すると、免疫グロブリンができにくくなり、異物に対する抵抗力が落ちます。その結果、感染症になりやすくなるというわけです。 なお、γ-グロブリン値が低下する病気に低γ-グロブリン血症というのがあり、臨床的には免疫不全を示します。 また骨髄移植患者などの免疫不全患者には感染症を予防するために、γ-グロブリンが投与されることもあります。

抗生物質に高度耐性化するMRSAは、非常にやっかいな菌です。 目次 抗生物質が効かないMRSA 特に発生率が高いICU内 抗生物質が効かないMRSA 本来病気を治す場所であるはずの病院で、逆に病気に感染してしまう。これが院内感染です。 あらゆる細菌やウイルスへの感染の危険がありますが、特に問題となっているのがMRSA(メチシリン耐性黄色ブドウ球菌)です。 これは命にかかわる黄色ブドウ球菌の中でも、抗生物質に対して強い耐性を示すので、抗生剤が効きません。しかも、メチシリンだけではなく、ペニシリン系やセフェム系、アミノグリコシド系、テトラサイクリン系など多剤に対して、高度耐性化するという非常にやっかいな菌です。 この菌は、感染源から患者や医療従事者の手やスリッパなどを介して感染します。空気中のチリやホコリに菌が付着して空気感染を起こすこともあります。 特に発生率が高いICU内 特に、ICU(集中治療室)では、ほかの場所の40倍も発生率が高くなっています。MRSAは免疫能力の低下している術後患者や老人に感染しやすく、循環器、呼吸器、消化器などさまざまな器官で感染症を引き起こします。 MRSAに対して強い抗菌力を持つとされていたバンコマイシンに対しても、最近、小規模ながらMRSAが耐性化したという報告があります。新しい抗生物質の開発と菌の耐性化という「いたちごっこ」を、どこかで断ち切るための研究が今盛んに行われています。





